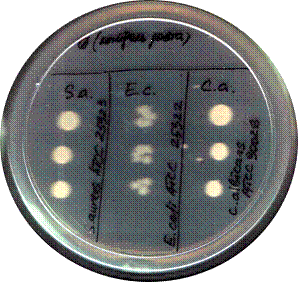

Антибактериальное серебросодержащее покрытие
Реферат
Прищепа Карина Александровна
Антибактериальное серебросодержащее покрытие
Ключевые слова:
серебросодержащее покрытие, наночастицы электронно-лучевым и лазерное
диспергирование исходных компонентов, биосовместимость, бактериоцидные
свойства.
Цель работы: совершенствование методики
вакуумного нанесения серебросодержащего антибактериального покрытия на очистной
картридж водяного фильтра.
Разработана методика нанесения антибактериальных
биосовместимых покрытий содержащих наночастицы серебра. Установлены высокие
антибактерицидные свойства таких покрытий к резистентным микроорганизмам и
водным грибкам. Определены оптимальные толщины синтезируемых покрытий по
критерию биосовместимости и высоких антибактериальных свойств. Разработан
технологический процесс нанесения антибактериальных покрытий на очистной
картридж водяного фильтра и рассчитан экономический эффект применения данного
покрытия
Ил. 18. Табл. 4. Библиогр.: 74 назв.
вакуумный антибактериальный серебро
грибок
Введение
В ХХI веке одной из угроз человечеству признано
распространение заболеваний, имеющих пандемический характер. Традиционные
возбудители таких заболеваний, мутируя на генетическом уровне, быстро
приспосабливаются к традиционным лекарственным препаратам и дезинфекционным
средствам и становятся резистентными к ним. В то же время современная наука и
промышленность, используя традиционные методы и технологии, эффективно
отреагировать на эти изменения не успевают. В ответ на эту угрозу человечеству
в последние десять лет в медицине и санитарии получило развитие новое
направление борьбы с инфекционными возбудителями - средства на основе биоцидных
наноразмерных частиц веществ.
Ученые и медики США, Европы, России, Японии,
Китая и многих других стран показали, что ряд металлов в виде наночастиц гораздо
более эффективны, чем все их традиционно используемые формы (в т.ч. ионы). В
отличие от существующих средств наночастицы серебра универсальны: они способны
уничтожить более 600 болезнетворных вирусов, бактерий и грибов, в то время как
любой из антибиотиков поражает не более 7 их разновидностей.
Дезинфекция является одним из важнейших
направлений в комплексе мероприятий по борьбе с инфекционными заболеваниями и
патогенной флорой. Ка уже было отмечено ранее, по мнению учёных многих стран
следующим поколением явятся дезинфектанты на основе наноразмерных структур,
имеющих биоцидные свойства широкого диапазона действия.
Одним из перспективных дезинфектантов являются
наночастицы серебра. Они позволяют бороться не только с такими опасными
болезнями, как СПИД, легионеллёз, птичий грипп и другие нетипичнные пневмонии,
гепатит, туберкулез, но и менее опасными, но широко распространенными и
причиняющими большое неудобство людям - сальмонеллёз, кишечные и
стафилококковые инфекции (в т.ч. вызываемые кишечной палочкой) и т.д. К
действию любого антибиотика микроорганизмы приспосабливаются за 7-10 лет. В то
же время не обнаружено ни одного случая, когда бы микроорганизмы приспособились
к действию наночастиц серебра, поскольку они атакуют микроорганизмы сразу по
нескольким направлениям.
Качество воды зависит от фильтрующих элементов.
Фильтр предназначен для очистки (без изменения минерального состава) воды от
взвешенных частиц, в том числе от частиц гидроокиси железа, солей тяжелых
металлов, марганца, мышьяка, остаточного алюминия, нитратов, нефтепродуктов, а
также устранения мутности, улучшения вкусовых качеств, уменьшения вероятности
проникновения болезнетворных бактерий. Основная проблема пористых фильтрующих
элементов в том, что поры забиваются снижается производительность фильтров, к
тому же они накапливают бактерии и водоросли, что ухудшает микробиологические
показатели воды.
Целью дипломного проектирования является:
совершенствование методики вакуумного нанесения серебросодержащего
антибактериального покрытия на очистной картридж водяного фильтра.
Задачи:
определить преимущества серебросодержащего
антибактериального покрытия сформированного из активной газовой фазы;
установить оптимальные толщины серебросодержащих
слоев по критерию биосовместимости и высоких антибактериальных свойств
1, Использование антибактериальных
серебросодержащих соединений
.1 Серебро
Серебро́ - это
элемент побочной подгруппы первой группы, пятого периода периодической системы
химических элементов Д. И. Дмитрия Ивановича Менделеева, с атомным номером 47.
Обозначается символом Ag (лат. Silver). Один из дефицитных элементов.
Простое вещество серебро (CAS- номер: 7440-22-4)
- ковкий, пластичный благородный металл серебристо-белого цвета.
Кристаллическая решётка - гранецентрированная кубическая. Температура плавления
- 963 °C, плотность - 10,5 г/см³.
Серебро является одним из тех
металлов, которые привлекли внимание человека еще в древние времена. Свое
название серебро ведет от санскритского слова "аргента", что значит
"светлый". От слова аргента произошло и латинское
"аргентум". Латинское название серебра "аргентум" как
древнегреческое "аргитос", шумерское "ку-баббар" и
древнеегипетское "хад", означает "БЕЛОЕ". История серебра
связана с алхимией, поскольку уже в те времена был разработан метод купелирования
серебра. На русском "серебро", на немецком "зильбер",
английском "сильвер" - эти слова восходят к древнеиндийскому слову
"сарпа", которым обозначали Луну и Серп (по аналогии с Луной) -
древнейшее орудие земледельца. Светлый блеск серебра несколько напоминает свет
Луны - серебро в алхимический период развития химии часто связывали с Луной и
обозначали знаком Луны [25]. В земной коре содержится около стотысячной доли
процента серебра. Основная его часть сосредоточена в минералах, где этот металл
находится в комплексах с серой, селеном, теллуром или галогенами. Основную
часть добываемого в мире серебра получают в результате комплексной переработки
полиметаллических руд, содержащих свинец, медь и цинк.
Чистое серебро - сравнительно
мягкий и пластичный металл. По удельной плотности (10,5 г/см3)
уступает лишь свинцу. По электропроводности же и теплопроводности серебро
занимает одно из первых мест. Плавится при относительно низкой температуре
(962°С), легко сплавляется со многими металлами; небольшие добавки меди к
серебру делают последнее более твердым, пригодным для изготовления различных
изделий.
.2 История использования антимикробных свойств
серебра
Издавна человечество использует противомикробные
свойства серебра при изготовлении предметов домашнего обихода. Благодаря его
дезинфицирующему действию вода или молоко, хранящиеся в серебряных кувшинах,
даже в жаркую погоду долго оставались свежими. Римляне хранили вино в
серебряной посуде, друиды использовали серебро для хранения еды, китайские
императоры ели серебряными палочками, чтобы сохранить здоровье. Первые
американские поселенцы чтобы сохранить молоко в дороге бросали в него
серебряные монеты. В церковных церемониях не случайно при причастии
используются серебряные кубки - это предотвращает распространение инфекций
среди паствы. Поныне использование серебряных столовых приборов считается не
только престижным, но и гигиеничным [18].
Исторически серебро использовали как в
металлическом, так и в ионном виде. Наиболее распространенный препарат ионного
серебра - нитрат серебра (AgNO3,
ляпис). Применение ляписа в медицине (примерно с XVII века, "адский
камень") основано на его антисептическом и прижигающем действии. В 1884
году акушер Карл Креде (Carl
Siegmund
Franz Crede)
предложил использовать 1% раствор нитрата серебра для лечения случаев Ophthalmia
neonatorum, вызванных Neisseria
gonorrhoeae [34]. Данный шаг
позволил сократить количество случаев "слепоты новорожденных" в
немецких клиниках и сопоставим по своей значимости разве что с введением в 1846
году в акушерскую практику Земмельвейсом (Ignaz
Philipp Semmelweis)
обязательной обработки рук [35], заложившему основы современной антисептики.
В обширном обзоре, посвященном антибактериальным
свойствам серебра, автор отмечает [15], что первые серьезные научные
исследования серебра как антисептика начаты Von
Behring в 1887 г, когда
было обнаружено, что 1:10000 раствор нитрата серебра за 48 часов разрушает
споры сибирской язвы. В 80-х годах XIX века швейцарский ботаник К.Наджели (Karl
Von Nageli)
обнаружил, что раствор, содержащий всего 0,01 мг/л серебра, является хорошим
альгицидом и ввел термин "олигодинамическое действие" (эффективность
в малых концентрациях) [87]. В 1970, при спонсировании NASA
были выполнены работы, подтверждающие открытие Nageli
in vitro,
что олигодинамичекое серебро (Ag+)
является высокоэффективным биоцидом в концентрации 50 мкг/л менее чем за 4 часа
и в концентрации 250 мкг/л менее чем за 2 часа [18]. Дополнительно было
показано, что увеличение концентраций серебра до уровня 10 мг/л приводит к
уменьшению времени проявления биоцидной активности до минут.
Л.А.Кульский [32], один из отечественных
пионеров использования соединений серебра (в том числе для целей
водоподготовки, с 1930), ещё в начале прошлого века показал, что
"серебряная вода" активнее хлора, хлорной извести, гипохлорита натрия
и других сильных окислителей, в 1750 раз сильнее карболовой кислоты и в 3,5
раза - сулемы (в одинаковой концентрации).
В наше время серебро используется для
дезинфекции пищевого и медицинского оборудования, очистки водных лечебниц,
бассейнов и различных водных систем. Во всем мире применяют серебряные фильтры
для очистки питьевой воды. В Японии с помощью серебра очищается
воздух.протестировало 23 различных метода очистки воды для космических кораблей
многоразового использования и выбрало систему серебряной фильтрации. На
Международной Космической Станции употребляется только серебряная вода.
Кроме того, превосходные антибактериальные
свойства серебра веками использовались при лечении множества воспалительных
заболеваний. Упоминание о его медицинском использовании можно найти в письменах
древних египтян [27].
В народной медицине стран Востока серебро
традиционно применяют уже более тысячи лет. Во время Первой Мировой войны
серебро использовалось для обеззараживания ран.
С открытием антибиотиков и сульфаниламидов
интерес к препаратам серебра несколько снизился. Но в последнее время
противомикробные свойства серебра вновь стали привлекать к себе внимание. Это
связано с ростом аллергических осложнений антибактериальной терапии,
токсическим действием антибиотиков на внутренние органы и подавлением
иммунитета, возникновением грибкового поражения дыхательных путей и
дисбактериоза после длительной антибактериальной терапии, а также появлением
устойчивых штаммов возбудителей к используемым антибиотикам.
В настоящее время серебро широко используется в
мире при лечении ожогов, заболеваний лор органов (при гриппе, ОРВИ, ангине и
др.), любых воспалительные заболевания полости рта (при пародонтозе,
гингивитах, стоматитах), бронхолегочных заболеваний, заболеваний
желудочно-кишечного тракта, для наружного применение (при гнойных ранах,
ожогах, дерматозах, экземе и др.), и в том числе в педиатрии. Серебро
применяется для уничтожения микроорганизмов, распространяющихся воздушно-капельным
путем, используется внутримышечно и внутривенно для уничтожения устойчивых к
антибиотикам бактерий, вирусов и грибков у людей и больных животных [21].
Широкий спектр противомикробного действия
серебра, отсутствие устойчивости к нему у большинства патогенных
микроорганизмов, низкая токсичность, отсутствие аллергенных свойств, а также
хорошая переносимость больными - способствовали повышенному интересу к серебру.
.3 Механизмы воздействия ионов серебра на
микробную клетку
Для объяснения ингибирующего действия серебра
было предложено три основных механизма: вмешательство в перенос электрона,
связывание ДНК, и взаимодействие с мембраной клетки. Формирование комплексов с
сульфогидрильными группами может инактивировать ферменты поверхности клетки, и
изменять процессы дыхания в мембране клетки. Связанные с ДНК ионы серебра
блокируют транскрипцию, а связанные с компонентами поверхности клетки прерывают
дыхание бактерии и синтез АТФ (аденозинтрифосфата) [13]. У Candida
albicans (но не у Escherichia
coli) необратимое
взаимодейстие ионов серебра с цистеиновым остатком в изомеразе фосфоманнозы
прерывает синтез стенок клетки, что в свою очередь ведет к потере незаменимых
питательных веществ [20]. Ионы серебра подавляют усвоение фосфатов, угнетают
функции ДНК, ингибируют трансмембранный транспорт органических и неорганических
веществ [19, 20]. Действие иона серебра на микробную клетку происходит в две
стадии: 1) адсорбция; 2) активный транспорт иона в клетку. До 90% поглощенных
ионов серебра задерживаются в мембране, метаболизм микробной клетки нарушается
в результате инактивации ферментов и белков-переносчиков (пермеаз). С помощью
электронной микроскопии показано, что под действием ионов серебра происходят
морфологические изменения в бактериальных клетках [25]; сульфадиазин серебра
также изменяет мембрану клетки бактерий Pseudomonas
aeruginosa [26]. Обработанные
клетки искажены по форме и имеют на поверхности пузыри. Штамм P.aeruginosa,
стойкий к AgSD, не
проявляет таких изменений. После обработки P.aeruginosa
нитратом серебра, ни одно из этих изменений не фиксируется. Авторы
предположили, что AgSD
действует в зоне внешней мембраны клетки.
В работе [21] авторы выясняли природу связи
серебро - полинуклеотиды на примере комплексов Ag(I)
+ (ДНК телячьего тимуса и РНК хлебопекарских дрожжей) в водных растворах с pH
7.1-6.6 при постоянной концентрации ДНК или
РКН и различных концентрацях Ag
(I). Спектроскопические результаты показали, что Ag
(I) формирует с ДНК
комплексы путем связывания катиона с гуанином (при низкой концентрации) и с
аденином (при более высоких концентрациях), но не с боковыми фосфатными
группами.
В работе [17] также изучали взаимодействие
сульфадиазина серебра с изолированной ДНК. Показано, что взаимодействие идет в
две конкурирующие стадии: слабая связь сульфадиазин-ДНК и сильная серебро-ДНК.
Полученный комплекс отличается от того, который образуется с ДНК в присутствии
нитрата серебра.
На примере P.Aeruginosa
и E.Coli
те же авторы показали [15] - даже не смотря на то, что добавление сульфадиазина
серебра (AgSD) к чистой
дезоксирибонуклеиновой кислоте (ДНК) ведет к образованию комплекса AgSD-ДНК,
подобные комплексы не обнаруживаются в бактериях, обработанных AgSD.
AgSD блокировал
макромолекулярные синтезы в бактериях; синтез ДНК был несколько более чувствительным
к этому ингибированию. Рибосомы, рибонуклеиновая кислота, и ДНК, выделенная из
обработанных клеток, были абсолютно нормальны. Бактерии с дефицитом полимеразы
ДНК не были более чувствительны к действию AgSD,
чем их родительский штамм. Радиоактивный AgSD
локализуется главным образом в цитоплазматической мембранной фракции
обработанных клеток.
Ионы серебра ингибируют поглощение и обмен
фосфатов в Escherichia
coli и взывают потерю
накопленного фосфата - так же, как маннита, сукцината, глутамина и пролина
[18]. Действие Ag+
блокируется тиолами и, в меньшей степени, бромидом. В присутствии N-этилмалеимида,
Ag+ не вызывал утечку
фосфата, но все еще ингибировал обмен внутриклеточным и внеклеточным фосфатом.
Еще один механизм действия ионов серебра, особенно в низких концентрациях,
представлен в [13]. Авторы показали, что низкие концентрации Ag+
вызывают массовую утечку протонов через мембрану Vibrio
cholerae, которая
заканчивается полной "деэнергизацией" и, с высокой степенью
вероятности, смертью клетки.
Авторами [14] была исследована способность
поглощать ионы Ag+,
Cd+2, Cu+2,
и La+3 из
растворов на примере Bacillus
cereus, B.subtilis,
Escherichia
coli и Pseudomonas
aeruginosa. Поглощение Ag+
из раствора бактериями происходит очень эффективно; из 1 мМ раствора было
удалено примерно 89 % общего количества, Ag+;
для Cd+2,
Cu+2 и La+3
эти значения были на уровне 12, 29, и 27 % общего количества соответственно.
Серебро, сорбировалось в виде дискретных коллоидных агломератов на поверхности
клетки и иногда в цитоплазме. Микробиоцидная способность металлов менялась в
том же порядке - Ag
> La > Cu
> Cd.
"Еще в 1919 году Заус проследил отложение
серебра в теле микроорганизмов и установил, что различные бактерии фиксируют
неодинаковое количество серебра в зависимости от своего размера. Так, дрожжи в
разведении 1:105 накапливали до 5% серебра по отношению к сухому
весу, а более мелкие бактерии (например, Escherichia
coli) - соответственно
меньше" [32]. В работе [20] количественные измерения разрушенных клеток
дрожжей после центрифугирования показали, что у Candida
utilis 90% Ag+
накапливается во фракции клеточных стен и мембран. Протопласты связывают ионы
серебра также быстро, как и целые клетки, однако гибнут гораздо быстрее.
В работе [25] изучали олигодинамическое действие
металлов - алюминия, сурьмы, висмута, кадмия, кобальта, меди, золота, железа,
свинца, марганца, ртути, никеля, платины, серебра, олова, титана, и цинка на Bacillus
subtilis (1 штамм), Enterobacteriaceae
(26 штаммов), Legionellaceae
(13 штаммов), Micrococcaceae
(6 штаммов), и Pseudomonas
aeruginosa (4 штамма). B.subtilis
и Legionellaceae показали
самую высокую восприимчивость. Восприимчивость различных бактерий к
олигодинамическому действию небольшого количества металлов значительно
отличается; непатогенные микрококки и стафилококки были более восприимчивы, чем
S.aureus.
Группа грам- отрицательных была самой стойкой.
Авторы [20] одними из первых предположили, что в
основе олигодинамического действия серебра лежит механизм взаимодействия c
тиоловыми группами ферментов. Для выяснения механизма действия и дезактивации
соединений серебра авторы [54] исследовали способность аминокислот (например,
цистеина CySH) и других
соединения (например, тиогликолята натрия), содержащих тиоловые группы (-SH),
нейтрализовать активность нитрата серебра против Pseudomonas
aeruginosa
PAOl. Аминокислоты с
дисульфидными связями также снижают активность серебра, за исключением
диметилового эфира L-цистина и
других аминокислот без сульфогруппы. При блокировании сульфогруппы цистеина путем
реакции с йодацетамидом, образующийся комплекс CyS-ацетамид
не способен нейтрализовать активность Ag+.
Химические исследования с использованием циклической вольтамперометрии
продемонстрировали, что высокие координационные числа (3:1) получаются при использовании
тиолсодержащих аминокислот и низкие (0-280-4) - с другими аминокислотами.
Тропность Ag+ к тиоловым
группам белков микробов также подтверждена методом аргентометрического
титрования с 0,1М раствором нитрата серебра [20]. Как микробиологические, так и
химические результаты демонстрируют, что взаимодействие Ag+
с тиоловыми группами играет существенную роль в инактивации бактерий [24, 26].
В работе [19] уточняется причина того, что протеины также снижают
антибактериальную активность серебра: "Ricketts
(1970) обнаружил, что катионы серебра проявляют бактерицидные свойства в воде,
но не в бульоне" - катионы серебра реагирует с сульфогидрильными группами
белков. С одной стороны, этот процесс и является одним из механизмов
антибактериальной активности серебра; с другой стороны, растворы
"Серебряных протеинов" антибактериальны только потому, что в них еще
присутствует небольшое количество серебряных ионов. Серебро химически связывает
скелетные и в функциональные протеины бактерий в виде органических сульфидов, а
также производит структурные изменения в бактериях и взаимодействует с
нуклеиновыми кислотами. Инактивация антимикробной активности серебра
тиогликолятом и тиосульфатом также отмечается в работе [20].
Среди металлов серебро обладает наиболее сильным
бактерицидным действием. При этом взаимодействие не самого металла, а его ионов
с клетками микроорганизмов вызывает их гибель.
Выявлено, что бактерицидный эффект
ионизированного серебра в 1750 раз сильнее карболовой кислоты и в 3,5 раза
сильнее сулемы и хлорной извести. Причем спектр противомикробного действия
серебра значительно шире многих антибиотиков и сульфаниламидов. Серебро
обладает более мощным антимикробным эффектом, чем пенициллин, биомицин и другие
антибиотики, и оказывает губительное действие на штаммы (разновидности)
бактерий, устойчивые к антибиотикам [29].
Серебро проявляет высокую бактерицидную
активность как по отношению к аэробным и анаэробным микроорганизмам (в том
числе и к разновидностям, устойчивым к антибиотикам), так и к некоторым вирусам
и грибам.
Исследования показали, что чувствительность
разных патогенных и непатогенных организмов к серебру неодинакова. Патогенная
микрофлора намного более чувствительна к ионам серебра, чем непатогенная.
Поэтому серебро действует избирательно, в большей степени уничтожая вредные
микроорганизмы.
Механизм действия серебра на микробную клетку
заключается в том, что ионы серебра поглощаются клеточной оболочкой микроба, в
результате чего его клетка остается
жизнеспособной, но при этом нарушаются некоторые ее функции, например деление
(бактериостатический эффект).
Таким образом доказано, что ионы серебра
оказывают различное противомикробное действие - от бактерицидного (способность
убивать микробы) до бактериостатического (способность препятствовать размножению
микробов) [56].
.4 Сульфадиазин серебра
В работе [29] авторы подробно
рассматривают достоинства и недостатки основных препаратов для лечения ожоговых
инфекций. Основные недостатки традиционного 0,5% раствора нитрата серебра
-гипотонический раствор крайне неустойчив, плохо проникает через некротическую
ткань (струп) и быстро инактивируется выделениями раны, а также возникает
опасность метгемоглобинемии из-за восстановления бактериями нитрата до нитрита.
"Нежелательные побочные эффекты раствора нитрата серебра ограничивают его
использование для лечения ожоговых инфекций большинством клиницистов в
настоящее время - сообщают авторы в [28]. -Мафенид ацетат, нитрофуразон или
хлоргексидин имеют свои недостатки. Для лечения ожоговых инфекций наилучшим препаратом
является сульфадиазин серебра (AgSD)".
В настоящее время для лечения
ожоговых инфекций широко применяют комплексную соль серебра с сульфамидным
соединением - сульфадиазин серебра. Особое внимание к сульфадиазинусеребра при
лечении ожоговых инфекций объясняется еще и тем фактом, что соединения серебра
(как и ПВП-йод) проявляют высокую активность против грамотрицательных
микроорганизмов. Известно, что после короткой фазы "стерильности", на
ранней стадии (до 24 часов) в зоне ожога в-основном преобладают
грамположительные микроорганизмы, которые в течение 3-7 дней сменяются
грамотрицательными [29].
Действие сульфадиазина серебра
было подробно изучено; "…для повышения ингибирования роста
грамотрицательных бактерий у пациентов с ожогами, охватывающими более 50 %
поверхности тела, Мопаго ввел в сульфадиазин серебра нитрат церия. Несмотря на
то, что предпринимались различные попытки создать более эффективные соединения
серебра, до настоящего времени сульфадиазин серебра все еще остается наиболее
широко используемым продуктом этого типа [28]".
Минимальные ингибирующие
концентрации (МИК) ионного серебра очень низки, но в присутствии различной
среды типа среды культуры, сыворотки или компонентов раны, МИК и МБК намного
выше [30]; они уменьшают антибактериальную эффективность серебряных ионов на
фактор 10 или больше. Белки и аминокислоты, особенно те, которые содержат
группу -ЗН, прочно реагируют с серебром (так же, как и фосфаты, хлориды, и
восстановители). Антибактериальная активность сульфадиазина серебра приблизительно
в пять раз ниже, чем ионного серебра. "Сульфадиазин серебра медленно
диссоциирует и выделяет ионы серебра и сульфадиазин в рану. При этом большая
часть серебра связывается компонентами раны, а не микроорганизмами. При
использовании на ране нитрата серебра, начальная высокая концентрация
серебряных ионов быстро исчерпывается без дальнейшего пополнения. МИК самого
сульфадиазина настолько высока, что количество сульфадиазина, выделившегося при
диссоциации сульфадиазина серебра, не достигает эффективных антибактериальных
уровней [31]".
В исследовании [31] Рассел
отмечает: "В той или иной форме серебро и его соединения долгое время
используются как антибактериальные средства. Самое важное из используемых в
настоящее время соединений серебра - сульфадиазин серебра, хотя металлическое
серебро, ацетат серебра, нитрат серебра, и "серебряный протеин"
внесены в Дополнительный Фармакопейный Список. В последние годы соединения
серебра использовались в-основном для предотвращения ожоговых инфекций, инфекций
глаз и уничтожения бородавок. Сульфадиазин серебра, AgSD
- по существу комбинация двух антибактериальных агентов, Ag+ и
сульфадиазина (SD).
Неоднократно обсуждался вопрос, возникает ли антибактериальный эффект AgSD
как простая сумма эффектов слагающих его компонентов или через синергическое
взаимодействие. AgSD
имеет широкий спектр активности и, в отличие от нитрата серебра, разрушает
поверхностные мембраны у восприимчивых к серебру (но не у стойких) бактерий. AgSD
связывается с компонентами клетки, включая ДНК. Бактериальное ингибирование
определяется главным образом взаимодействием с основными парами в спирали ДНК,
что блокирует транскрипцию. Точно так же его антифаговые свойства объясняют
тем, что AgSD связывает
ДНК фага. Все же механизм действия серебра до конца не ясен".
Впервые в клиническую практику
сульфадиазин серебра (AgSD)
ввел Фокс [32], [33]. Последующие многочисленные исследования данного препарата
подтвердили его антимикробную активность против широкого спектра патогенных
организмов.
Например, в [34] изучали роль
серебра и сульфадиазина в механизме действия сульфадиазина серебра на ожоговые
инфекции. Показано, что сульфадиазин в
низких концентрациях сам по себе не действовал как антибактериальный агент, но
проявлял определенный синергизм в комбинации с МИК сульфадиазина серебра. С
учетом того, что с бактерией связывается именно серебро, а не сульфадиазин,
эффективность сульфадиазина серебра видимо определяется замедленной реакций
ионов серебра с сывороткой и другими жидкостями, содержащими хлорид натрия, что
обеспечивает медленное, но стабильное высвобождение ионов серебра в
обрабатываемую зону.
В работе [35] показано, что 657
различных штаммов бактерий 22 различных типов были ингибированы концентрациями,
которые могут быть легко получены при наружном использовании в клинике. Штаммы,
стойкие к сульфадиазину или большинству антибиотиков были чувствительны к
сульфадиазину серебра.
В [36] авторы пишут: "В
100% случаев обработки язв кремом сульфадиазина серебра (15 пациентов), в
течение трехнедельного испытательного периода бактериальный уровень был
уменьшен до 105 или меньше на грамм ткани - по сравнению с 78.6%
пациентов, которых обрабатывали физиологическим раствором соли (14 пациентов) и
63.6% пациентов, которых обрабатывали раствором ПВП-йода (11 пациентов)".
Авторы [37] исследовали
достоинства и недостатки серебро- и йодсодержащих препаратов для лечения
ожоговых ран. Показано, что 1%-ый сульфадиазин серебра (в виде крема, повязки и
пр.) аналогичен по своему действию ПВП-йоду; незабинтованная рана образует
меньше келоидных рубцов. При обработке модельных ожоговых ран у свиней
сульфадиазин серебра совместно с антибактериальной активностью повышает степень
эпителизации на 28 % [38]. Авторы также утверждают, что в данной модели ран
ПВП-йод вообще не влияет на степень заживления.
.5 Коллоидное Серебро
Ученые обнаружили, что самые важные
"жидкости" организма являются коллоидными в природе - из взвешенных
мелких частиц. Кровь, например, несет питательные вещества и кислород к
соматическим клеткам. Это привело к исследованиям коллоидного раствора серебра
(электрические серебряные атомы). Электро-коллоидный процесс, как известно,
является лучшим методом, который используется для производства коллоидного
серебра. Коллоидное серебро проявляет сильный, естественный антибиотический и
профилактический эффекты против инфекций. Оно действует как катализатор, т.е.
присоединяясь, повреждает фермент, который одноклеточным бактериям, вирусам и
грибам необходим для их кислородного метаболизма. Результат - разрушение
микроорганизмов, вызывающих болезни в теле и в пище.[54, 25]
1.6 Аргария
В 1977 г описан случаи
аргирии,(в руководстве по токсикологии металлов [39] отмечается, что
"аргирия - бурая или черно-серая пигментация кожи, слизистых оболочек,
тканей внутренних органов и глаз, обусловленная отложением в них серебра если
не принимать во внимание эстетический аспект, это состояние считают безопасным
для достижения аргирии при хроническом воздействии требуется полная доза около
1-8 гАд. Доза, необходимая для возникновения аргирии при приеме пищи несколько
выше, около 1-30 г растворимых солей"),вызванный употреблением солей
серебра или коллоидного серебра, который был принят за сердечно-сосудистое
заболевание [40]; с тех пор случаи передозировки соединений серебра и возникновения
аргирии фиксируют достаточно тщательно. В [40] описан случай аргирии из-за
неконтролируемого продолжительного (2,5 года) применения аппликаторов нитрата
серебра на слизистой оболочке рта. Пациентка имела повышенную пигментацию кожи
и, по результатам гастродуоденоскопии и лапаротомии, - брюшных внутренних
органов. При этом системной токсичности серебра отмечено не было.
Статья [41] сообщает о
клинически отмеченных случаях, при которых 30 рабочих длительное время
контактировали с нитратом и оксидом серебра. У шестерых из них зарегистрирована
аргирия, и у 20 - аргироз (отложение серебра в глазах). Как часть экспертизы
был замерен уровень содержания серебра в крови. Результаты этой экспертизы
вообще подтверждают неопасный характер аргирии, хотя проблема избыточного
серебра, вызывающего декремент почечной функции и "куриную слепоту",
до конца не урегулирована. Большое влияние на развитие аргирииоказывают
индивидуальная предрасположенность организма к серебру, качественные и
количественные показатели иммунитета и другие факторы. Косвенным
доказательством этого может служить тот факт, что дозы, которые приводят к
аргирии, различны.
ВОЗ определила для серебра
максимальную дозу, которая не вызывает обнаруживаемого вредного воздействия на
здоровье человека - 10 грамм. Таким образом, по методике ВОЗ человек,
"съевший и выпивший" за свою жизнь (70 лет) суммарно 10 грамм
серебра, гарантированно не должен иметь из-за этого никаких проблем со
здоровьем. На основе этой величины и были сделаны рекомендации по толерантному
(переносимому) содержанию серебра в питьевой воде - 100 мкг/л. Такая
концентрация за 70 лет жизни даст половину уровня NOAEL, что заведомо безопасно
для здоровья. По данным отечественных "Санитарных Норм и Правил" ПДК
серебра в питьевой воде - 50 мкг/л. Согласно рекомендации управления по охране
окружающей среды (ЕРА), содержание серебра в дезинфицирующих препаратах для
использования в больницах, других медицинских учреждениях, в быту и
промышленности не должно превышать 32 мг/л. Американская
конференция правительственных индустриальных гигиенистов установила различные
допустимые пороговые пределы в воздухе для металлического серебра (0.1 мг/м 3)
и для растворимых соединений серебра (0.01 мг/м3). Несмотря на то,
что металлическое серебро по-видимому наименее токсично, допустимый предел
экспозиции (РЕ1_) рекомендованный американским национальным институтом
проф-безопасности и здоровья (National Institute for Occupational Safetyand
Health ) - 0.01 мг/м3 для всех форм серебра
[70]. По отечественным нормам ГН 2.1.6.1339-03, ОБУВ серебра также 0.01 мг/м3.
1.7 Сравнительная характеристика галогенидов
серебра, металлического серебра и водорастворимыми солями серебра
Вообще, применение галогенидов
серебра в качестве антисептических препаратов имеет ряд существенных преимуществ
перед металлическим серебром и водорастворимыми солями серебра. Во-первых, само
по себе металлическое серебро не обладает антимикробными свойствами, активность
подобных коллоидных систем определяется наличием неопределенного количества
ионов - т.е. окислением поверхности золя; данный процесс зависит от внешних
факторов и трудно поддается контролированию. Во-вторых, все коммерческие и
клинические препараты "электрохимического" серебра изготавливаются в
присутствии электролита, в качестве которого используют в-основном избыток
поваренной соли NaCl;
совершенно очевидно, что полученный препарат представляет собой раствор хлорида
серебра и/или комплексного соединения NапАgСl(п+1)
переменного
состава и концентрации. Наконец, водорастворимые соли имеют тенденцию
восстанавливаться до металлического серебра (окрашивать поверхность),
достаточно токсичны и вызывают аргирию [21].
1.8 Отличия антибактериального серебра от
серебра применяемого в повседневной жизни
Чтобы понять, чем антибактериальное серебро отличается
от серебра, привычного в быту, надо сделать несколько замечаний.
"Нанос" в переводе с греческого - "карлик". Эта приставка
используется для обозначения миллиардной доли чего-либо, в данном случае -
метра. Курсы физики и химии дают довольно полное представление о веществе в
форме изолированных атомов и молекул, а также в конденсированном (сплошном)
состоянии - в форме жидкостей и кристаллов. Для последнего состояния характерно
отсутствие зависимости физико-химических свойств и характеристик вещества от
геометрических размеров образца, числа атомов или молекул в нем. Каждый на
практике может наблюдать это на примере воды. Температура кипения воды в
кофейной чашке составляет 100°С, при этой же температуре будет кипеть вода и в
большом котле емкостью несколько кубометров. Это потому, что размеры образца в
такое огромное число раз превосходят межатомные расстояния, что любая
зависимость этих свойств и характеристик от мелких, локальных подробностей
взаимного расположения атомов и их полного числа в практическом плане
совершенно пропадает [3].
Человечество с древних времен пыталось решить
эту проблему на примере дробления кристаллов. Всем известный кристалл
поваренной соли имеет форму куба. До какого предела можно его дробить, чтобы
кристалл сохранил исходную форму? Существует ли кристалл минимального
критического размера, свойства которого не отличаются от свойств массивного
кристалла? Наука дала положительный ответ на этот вопрос. Дальнейшее уменьшение
геометрических размеров в большинстве случаев приводит к скачкообразному
изменению какого-либо его физического или химического свойства. Такие
кристаллы, имеющие размеры, близкие к критическому, выделили в особую группу
материалов - нанокристаллы. Они, в свою очередь, по своим свойствам отличаются
и от изолированных атомов или молекул, их составляющих. Что же это за масштабы?
Разумеется, не существует четко определенного граничного размера, о котором
можно сказать: больше - это конденсированная фаза, а меньше - наночастица. Но
некоторый типичный масштаб все же есть. Он условно равен 100 нм. Начиная с
этого размера, агломерат атомов или молекул уже ведет себя как наночастица.
Наиболее ярко размерные эффекты проявляются на дискретных наночастицах, не
образующих компактных наноматериалов, а также в нанослойных структурах. Было
обнаружено, что серебро в наноразмерном состоянии радикально отличается по
своим бактерицидным свойствам от окружающих нас в быту серебряных изделий и
предметов [1].
1.9 Особенности наночастиц серебра и методов
формирования их
На сегодняшний день антибактериальное
серебросодержащие покрытие - это наиболее коммерциализированный за рубежом
нанопродукт. В основе новых технологий - использование мощных противомикробных
свойств наночастиц серебра. Поскольку наночастица в среднем в 2 тысячи раз меньше
диаметра человеческого волоса, она легко взаимодействует с вызывающими болезни
микроорганизмами, мешая им расти-размножаться или вовсе убивая их.
Бактерицидные добавки на основе наночастиц серебра являются одним из последних
достижений мировой науки в области нанобиотехнологий [2].
Наночастицы серебра синтезировались с помощью
конденсации инертным газом и cocondensation методы. Оба метода основаны на
испарении металла в атмосфере инертного газа с последующим охлаждением для
образования ядра и роста наночастицы. Размер и морфология наночастиц были
проанализированы с помощью микроскопа электронной передачи. Стабильность
наночастиц была исследована, действием окружающими условиями в течение одного
месяца.
Антибактериальная эффективность наночастиц была
исследована, вводя частицы в раствор, содержащий бактерии. Наночастицы серебра,
как показали исследования, проявляют антибактериальные эффекты в низких
концентрациях. Антибактериальные свойства обусловлены суммарной площадью
поверхности наночастицы. Меньшие частицы с большим отношением площади
поверхности к объему обладают более эффективной способностью антибактериального
действия. Наночастицы были полностью токсичными для E. Coli даже в таких низких
концентрациях как 8 мг Ag/cm2т.
Наночастицы благородных металлов имеют большие
перспективы применения не только в различных каталитических системах, но и в
оптических сенсорных устройствах, основанных на поверхностном плазмонном
резонансе (ППР). Это относится, главным образом, к биосенсорам, для которых
необходима большая химическая инертность наночастиц по отношению к
биологическим объектам. Из известных методов формирования наночастиц
благородных металлов на подложках наиболее предпочтительными являются вакуумные
методы получения. Однако к недостаткам этого метода следует отнести плохую
адгезию благородных металлов к большинству диэлектрических материалов. Для
повышения адгезии в этом случае, как правило, используют тонкий адгезионный
подслой, который может влиять на характеристики ППР [9]. Известно также [11],
что облучение тонкопленочного металлического покрытия на диэлектрической
подложке импульсным ионным пучком наносекундной длительности приводит к
образованию на поверхности подложки частиц металла различного размера и формы.
.10 Опасность наночастиц
- общее название для всех продуктов распада,
производимых наноприборами или наноматерилами в течение производственного
процесса. Эти продукты распада могут быть очень опасным из-за размеров. Они
могут находиться в воздухе, легко проникать в животные клетки, что может
вызвать неожиданный эффект. Большинство синтезированных
человеком наночастиц не появляется в природе, и живущие
организмы
могут не иметь представления о наноотходах. Чем меньше частица, тем больше
отношение ее площади поверхности к объему и выше ее химическая реактивность и
биологическая деятельность. Большая химическая активность наночастиц
наблюдалась при увеличенном производстве реактивных кислородных форм, включая
свободные радикалы. Реактивные кислородные формы были обнаружены в разных
формах наноматериалов, включая углеродные фуллерены, углеродные нанотрубки и
наночастицы окисленных металлов. Реактивные кислородные формы и
свободно-радикальная продукция - одни из основных предпосылок токсичности
наночастиц; это может привести к повышенному окислению, последовательному
повреждению белков, мембран и ДНК. Наночастицы оказались ядовитыми для
человеческой ткани и клеточной культуре, приводя к увеличенному окислению,
спонтанному выброса цитокина и смерти клетки. В отличие от больших частиц,
наночастицы могут влиять на митохондрии и ядро клетки. Размер - ключевой
фактор, определяющий токсичность наночастицы. Другие свойства наноматериалов,
которые влияют на токсичность - химический состав, форма, поверхностная
структура, способность к растворению, агрегации [18].
Существенные проблемы с окружающей средой,
здоровьем могли бы возникнуть с развитием нанотехнологий под действием
небольшого количества влияния наночастиц. Однако сама природа создает все виды
нанообъектов, поэтому вероятной опасности наночастицы не представляют, но
раннее нетоксичные материалы, в качестве наночастицы, могут стать опасными при
попадании в организм. Социальные риски, связанные с развитием нанотехнологий
включают возможность использования их в военных целях. Расширенные возможности
наблюдения через нанодатчики также вызывает беспокойство у защитников прав
частной жизни. В обсуждении проблемы отношения к нанотехнологии имеет место -
используется для того, чтобы показать этические, юридические, и социальные
значения нанотехнологий [18].
.11 Снижения токсичности антибактериальных
серебросодержащих покрытий
Серебро (особенно в ионной
водорастворимой форме) токсично для водных организмов (аквакультур) [21, 22]. В
то же время "токсичность серебра по отношению к млекопитающим сравнительно
низка. У человека в течение 24 часов может наблюдаться концентрация Ag
в сыворотке крови до 600 мкг/л и в моче 1100 мкг/л без клинических
последствий... Наиболее важным является тот факт, что нет сообщений ни о какой
мутагенной или канцерогенной активности соединений серебра" [23].
Токсичность антибактериальных наночастиц серебра
может быть снижена.
Химики Университета Хельсинки (University of
Helsinki) создали новые наночастицы серебра, стабилизированные полимером.
Результат их работы очень важен, так как благодаря своим антибактериальным
свойствам наночастицы этого металла используются в текстиле, напольных
покрытиях, красках, несмотря на то, что последствия их воздействия на здоровье
не полностью изучены. Финские исследователи считают, что их отрицательное
влияние
может быть снижено благодаря химической связи наночастиц с полимером.
Наночастицы - тема для обсуждений, как в научных
кругах, так и в среде обывателей. Антибактериальные свойства серебра, с другой
стороны, были известно уже давно и используются во многих областях.
Супермаркеты продают множество продуктов с добавлением серебра или его
наночастиц. Широко доступны коллоидные растворы серебра для внутреннего
применения, а также средства гигиены и даже перевязочный материал, содержащие
серебро.
Ученые обнаружили, что самые важные
"жидкости" организма являются коллоидными в природе - из взвешенных
мелких частиц. Кровь, например, несет питательные вещества и кислород к
соматическим клеткам. Это привело к исследованиям коллоидного раствора серебра (электрические
серебряные атомы). Электро-коллоидный процесс, как известно, является лучшим
методом, который используется для производства коллоидного серебра. Коллоидное
серебро проявляет сильный, естественный антибиотический и профилактический
эффекты против инфекций. Оно действует как катализатор, т.е. присоединяясь,
повреждает фермент, который одноклеточным бактериям, вирусам и грибам необходим
для их кислородного метаболизма. Результат - разрушение микроорганизмов,
вызывающих болезни в теле и в пище [54, 25].
В Университете Хельсинки разрабатывается метод,
который может стать решением проблемы снижения токсичности серебра. Наночастицы
производятся различными методами, основанными на разложении солей металла, в
данном случае нитрата серебра, в присутствии стабилизирующего компонента.
Стабилизированные полимером наночастицы успешно получены в Лаборатории
полимерной химии (Laboratory of Polymer Chemistry) Университета Хельсинки. В
работе оказались бесценными опыт ученых лаборатории, полученный при разработке
наночастиц золота, и квалификация исследователей из Школы Науки и Технологии
Университета Аалто (School of Science and Technology of the Aalto University) и
их европейских партнеров.
При создании наночастиц хельсинкские ученые
стабилизирующим компонентом сделали полимер, содержащий тиольную группу.
Известно, что тиольные группы эффективно взаимодействуют с серебром, что
приводит к стабилизации коллоида серебряных наночастиц и связыванию их с
полимером. Сам полимер - это мягкий, резиноподобный акрилат, содержащий растворимый
в воде блок, позволяющий ионам серебра высвобождаться из гидрофобного покрытия.
Идея состоит в том, чтобы покрытия или их компоненты создавать именно из таких
наночастиц.
На сегодня выдвинуты различные гипотезы
механизмов токсичности серебра для микроорганизмов. Продемонстрировано, что
ионы серебра реагируют с тиольными группами внутриклеточных белков. Есть
подтверждения тому, что ионы серебра повреждают ДНК, ингибируя ее репликацию.
Свойство серебра образовывать крайне малорастворимые соли также рассматривается
как один из механизмов воздействия на клетку. Образование внутриклеточными
ионами хлора нерастворимой соли - хлорида серебра - в цитоплазме клеток
подавляет процессы клеточного дыхания. Хорошо известна антибактериальная
активность и наночастиц серебра, особенно по отношению к грамотрицательным
бактериям. Их эффективность определяется образованием ионов серебра и их
проникновением в клетку микроорганизма.
В целом серебро, его ионы и наночастицы
считались вполне безвредными для людей. Однако последнее исследование показало,
что наночастицы проникают и в клетки млекопитающих и повреждают геном. Есть
даже основания полагать, что они могут активно проникать в клетки с помощью
эндоцитоза. Внутри клетки наночастицы окисляются перекисью водорода, образующейся
там в процессе клеточного дыхания, что приводит к образованию ионов серебра,
увеличивая их токсичность. Таким образом, вполне обоснованным является вывод о
том, что наночастицы оказывают цитотоксичный и генотоксичный эффекты. Более
того, доказано, что они могут проникать в кожу через кожные поры и железы.
Повреждения кожи облегчают их проникновение. Очень
важно, поэтому, чтобы покрытия, содержащие наночастицы, не выделяли их. По
мнению финских ученых, эффект покрытия должен основываться на выделении ионов
серебра. Следовательно, наночастицы должны быть связаны с покрытием настолько
прочно, насколько это возможно, что сможет уменьшить возможные отрицательные
последствия их применения. В
большинстве своем авторы сходятся во мнении, что, в отличие от солей других
тяжелых металлов, серебро не является опасным при наружном и медицинском
внутреннем применении. Многие ученые предупреждают о риске неумеренного
использования различных продуктов, продвигаемых на рынок в виде
биологически-активных добавок: "серебряных протеинов", коллоидных
растворов и других коммерческих (немедицинских) препаратов серебра [24].
.12 Способы нанесения серебросодержащих покрытий
На сегодняшний день известно много
технологических приемов (нанометодов) получения наносеребра.
Наиболее
общей кинетической закономерностью формирования наноразмерных частиц является
сочетание высокой скорости зарождения кристаллической фазы с малой скоростью ее
роста. Именно эти особенности синтеза наночастиц определяют технологические
пути его осуществления.
Все методы получения наночастиц можно разделить
на две большие группы. Первая объединяет способы, позволяющие получать и
изучать наночастицы, но на основе этих методов трудно создавать новые
материалы. Сюда можно отнести конденсацию при сверхнизких температурах,
некоторые варианты химического, фотохимического и радиационного восстановления,
лазерное испарение.
Вторая группа включает методы, позволяющие на
основе наночастиц получать наноматериалы. Это в первую очередь различные
варианты механохимического дробления, конденсация из газовой фазы,
плазмохимические методы, вакуумные методы и др.
Такое разделение методов является относительно
условным. Но отражает еще одну их особенность: получение частиц путем
укрупнения отдельных атомов и агрегации, или подход "снизу", и
различные варианты диспергирования, или подход "сверху". Первый
подход характерен в основном для химических методов получения наноразмерных
частиц, второй для физических методов. Получение наночастиц путем укрупнения
атомов позволяет рассматривать единичные атомы как нижнюю границу нанохимии.
Верхняя граница определяется количеством атомов в кластере, при котором
дальнейшее увеличение размера частицы не ведет к качественным изменениям
химических свойств.
Т.О. методы получения наночастиц серебра
разделяют на химические, физические, механические и биологические.
Классификация методов получения наночастиц
серебра, представлена в таблице 1.

Химические методы синтеза включают различные
реакции и процессы, в том числе процессы осаждения, термического разложения или
пиролиза, газофазных химических реакций, восстановления, гидролиза,
электроосаждения, а также гальванический метод. Регулирования скоростей
образования и роста зародышей новой фазы осуществляется за счет изменения
соотношения количества реагентов, степени пересыщения, а также температуры
процесса. Как правило, химические методы многостадийные и включают нейкий набор
из вышепоименованных процессов и реакций.
Физические методы получения наночастиц серебра.
Способы испарения
(конденсации), или газофазный синтез получения нанопорошков металлов, основаны
на испарении металлов, сплавов или оксидов с последующей их конденсацией в
реакторе с контролируемой температурой и атмосферой. Фазовые переходы пар -
жидкость - твердое тело или пар - твердое тело происходят в объеме реактора или
на поверхности охлаждаемой подложки или стенок.
Механические методы.
Способы измельчения материалов
механическим путем в мельницах различного типа - шаровых, планетарных,
центробежных, вибрационных, гироскопических устройствах, аттриторах и
симолойерах. Аттриторы и симолойеры - это высокоэнергетические из-мельчительные
аппараты с неподвижным корпусом-барабаном с мешалками, передающими движение
шарам в барабане. Аттриторы имеют вертикальное расположение барабана,
симолойеры - горизонтальное. Измельчение размалываемого материапа
размалывающими шарами в отличие от других типов измельчающих устройств
происходит главным образом не за счет удара, а по механизму истирания. Емкость
барабанов в установках этих двух типов достигает 400...600 л.
Биологическиеметоды получения наночастиц
серебра.
Наноматериалы могут производиться и в
биологических системах. Во многих случаях живые организмы, например, некоторые
бактерии и простейшие организмы, производят минеральные вещества с частицами и
микроскопическими структурами в нанометровом диапазоне размеров.
В процессах биоминерализации действуют механизмы
тонкого биохимического контроля, в результате чего производятся материалы с
четко определенными характеристиками.
Живые организмы могут быть использованы как
прямой источник ультрадисперсных материалов, свойства которых могут быть
изменены путем варьирования биологических условий синтеза или переработки.
Ультрадисперсные материалы, полученные
биохимическими методами синтеза, могут быть исходными материалами для некоторых
уже опробованных и известных методов синтеза и обработки наноматериалов, а
также в ряде технологических процессов. Пока работ в этом направлении
исследований немного, но уже можно указать ряд примеров получения и
использования биологических наноматериалов. Наиболее
популярные методы синтеза наночастиц серебра связаны с применением
электрохимических, гальванических и вакуумных технологий.
Электрохимические
методы синтеза наносеребра в жидких средах используются уже в течение 76 лет.
Как это ни парадоксально сегодня звучит, самая
первая в мире промышленная технология синтеза наносеребра в жидких средах
создана в Украине. В 1930 году выдающийся украинский ученый, академик АН УССР,
профессор Леонид АдольфовичКульский впервые разработал метод обеззараживания
питьевой воды электролитическими растворами серебра. Хотя серебряная вода была
известна в глубокой древности, начало систематическому применению серебра для
обеззараживания и дезинфекции воды положил именно профессор Л.А. Кульский.
Зарубежные коллеги пришли к его результатам через несколько лет.
Его
работы в этой области широко признаны и общеизвестны. Книга Л.А. Кульского
"Серебряная вода" с 1946 года переиздавалась более 10 раз.
Вместе
с тем надо отметить, что в период работы над техникой очистки питьевой воды от
вредных веществ, и особенно от болезнетворных микроорганизмов, идеи
нанотехнологий и наноматериалов еще не были сформулированы. Поэтому
интерпретация результатов исследований велась в рамках существовавших тогда
представлений об образовании ионных растворов серебра в воде. Предполагалось,
что имеет место угнетающее влияние ионов серебра непосредственно на бактерии.
По-видимому, в действительности Л.А. Кульский и его последователи имели дело со
слабыми коллоидными растворами серебра в воде. Роль коллоидных частиц выполняли
наночастицы (кластеры) серебра числом от нескольких атомов до нескольких сот
или агломераты кластеров. Именно такие наночастицы серебра, как показывают
исследования последних двух лет, проведенные в техасском и мексиканском
университетах, обладают самой мощной бактерицидной активностью. Поэтому роль
наночастицв серебряной воде оказывалась недооцененной до самого последнего
времени. Можно отметить что кластеры серебра с числом атомов 13 кардинально
меняют магнитные свойства. То есть мир наночастиц серебра только начинает
приоткрывать свои тайны. Пока же можно констатировать, что они являются
эффективным антибактериальным средством для обеззараживания широкого спектра различных
жидких сред.
Гальвонический метод нанесения
серебросодержащего покрытия.
Серебряные покрытия наносят
способами погружения, полива и пневмораспыления. Первыйиз них применяют при
серебрении деталей небольших размеров, второй - при нанесении покрытий на
большие ноские поверхности, преимущественно из стекла, и третий-при обработке
больших как плоских, так и рельефных поверхностей из самых разнообразных
материалов (например, стекла - в производстве зеркал, лаковых дисков при
изготовлении грампластинок, моделей из кожи, поливинилхлорида - в производстве
пресс-форм, используемых при выпуске обуви из пластизоля). Наиболее экономичным
и производительным является способ получения покрытия пневмораспылением. Он
позволяет получать, беспористое однородное покрытие с высоким коэффициентом
отражения [6].
Следующим популярные способы синтеза наночастиц
и нанослоев серебра - это вакуумные нанотехнологии. В этом случае массивный
образец серебряной мишени переводится в состояние пара или плазмы с получением
отдельных атомов или ионов, последующая конденсация которых приводит к
образованию большого числа стабильных серебряных наночастиц (нанопорошка) или
нанослоев. Например, наночастицы могут состоять всего из нескольких десятков
атомов серебра. Такими наночастицами или нанослоями
серебра
(в отличие от наночастиц в жидких средах) можно легко оперировать. Их можно
вводить в качестве бактерицидных добавок в продукты или изделия. Нанослои
серебра можно легко наносить на любые подходящие поверхности твердых тел и в
дальнейшем использовать их в качестве функциональных бактерицидных покрытий
[2]. На этих наноразмерных системах серебра и остановимся.
Выводы
Издавна человечество использует противомикробные
свойства серебра. В наше время серебро используется для дезинфекции пищевого и
медицинского оборудования, очистки водных лечебниц, бассейнов и различных
водных систем. Применяют серебряные фильтры и для очистки питьевой воды. В
настоящее время применяют серебро в виде наночастиц - это позволяет в сотни раз
снизить концентрацию серебра с сохранением всех бактерицидных свойств
(способность убивать микробы) и бактериостатических (способность препятствовать
размножению микробов), так как наносеребро :
обладают высокой антимикробной
активностью, в т.ч. способны адаптированные к внешним воздействиям
микроорганизмы (подавлять наиболее или их видоизмененные формы). Серебро
убивает приблизительно 650 различных микроорганизмов, вызывающих болезни;
имеют полный спектр антимикробного
действия (бактерии, вирусы, грибы) и подавления патогенной микрофлоры (споры);
не оказывают деструктирующего влияния
на материалы обрабатываемых изделий;
не содержат хлорсодержащих компонентов;
обеспечивают безопасность здоровья
человеку при рекомендуемых режимах обработки;
- экологически безопасны - не загрязняют
окружающую среду вредными химическими соединениями.
Известно достаточное количество методов
получения наночатиц серебра, которые можно разделить на химические, физические,
механические и биологические. Наиболее предпочтительным является физический
метод нанесения, а именно вакуумный, позволяющий наносить наночастицы серебра
заданной концентрации на подложку любой природы, в том числе и на пористые
материалы
2.
Объекты и методы исследований
2.1 Объекты исследований
В дипломном проекте объектами
исследования являются покрытия формируемые из активной газовой фазы,
образованные электронно-лучевым или лазерным диспергированием исходных
компонентов: полимера (полиуритан, фторопласт) и антибиотика (ципрофлоксацин,
гидрохлорид ПГМГ и серебросодержащее соединения (соли органических и
неорганических кислот))
Приведем характеристику
выбранных материалов.
Серебро́
- элемент
побочной подгруппы первой группы, пятого периода периодической системы
химических элементов Д. И. Менделеева, с атомным номером 47. Обозначается
символом Ag (лат. Argentum). Простое вещество серебро - ковкий, пластичный
благородный металл серебристо-белого цвета. Кристаллическая решётка -
гранецентрированная кубическая. Температура плавления - 960 °C, плотность -
10,5 г/см³. Серебро, будучи
благородным металлом, отличается относительно низкой реакционной способностью,
оно не растворяется в соляной и разбавленной серной кислотах. Однако в
окислительной среде (в азотной, горячей концентрированной серной кислоте, а
также в соляной кислоте в присутствии свободного кислорода) серебро
растворяется, растворяется оно и в хлорном железе, что применяется для
травления.Серебро также легко растворяется в ртути, образуя амальгаму (жидкий
сплав ртути и серебра).
Серебро не окисляется
кислородом даже при высоких температурах, однако в виде тонких плёнок может
быть окислено кислородной плазмой или озоном при облучении ультрафиолетом. Во
влажном воздухе в присутствии даже малейших следов двухвалентной серы
(сероводород, тиосульфаты, резина) образуется налёт малорастворимого сульфида
серебра, обуславливающего потемнение серебряных изделий.
В обзоре [67] автор пишет, что "соединения
серебра широко используются сегодня как эффективные антибактериальные агенты
для борьбы с патогенами (бактерии, вирусы и эукариотныемикроорганизмы) в
клинике и для гигиены в быту. Катионы серебра (Аg+) микробиоцидны
при низких концентрациях и обычно используются для обработки ожоговых инфекций,
ран и язв. Ag используется для покрытия катетеров с целью предотвращения
образования биологических пленок, в изделиях гигиены, включая кремы для лица и
зубные пасты (цеолит, обработанный солями серебра - в том числе йодидом -
используют как бактерицидный наполнитель в составе зубных паст
[68]),
как пищевая добавка "нетрадиционной медицины", в супермаркетах для
мытья овощей, в фильтрах для очистки воды, воздуха (в Японии) и даже для
изготовление "антимикробной жевательной резинки" (содержащей от 0,05
до 50% ионов серебра на керамическом носителе, патент США, либо хлорид серебра
на ультрадисперсной 0.01-1 мкм двуокиси титана [69])
Полиуретаны - гетероцепные
полимеры, макромолекула которых содержит незамещённую и/или замещённую
уретановую группу -N(R)-C(O)O-, где R = Н, алкил, арил или ацил. В
макромолекулах полиуретанов также могут содержаться простые и сложноэфирные
функциональные группы, мочевинная, амидная группы и некоторые другие
функциональные группы, определяющие комплекс свойств этих полимеров.
Полиуретаны относятся к синтетическим эластомерам и нашли широкое применение в
промышленности благодаря широкому диапазону прочностных характеристик.
Используются в качестве заменителей резины при производстве изделий, работающих
в агрессивных средах, в условиях больших знакопеременных нагрузок и температур.
Диапазон рабочих температур - от −60° С до +80° С.
Основные технические характеристики
полиуретанаДесмопан 300 (Desmopanн 300):
- Прочность при разрыве, не менее30 МПа
- Относительное удлинение, не менее370 %
Остаточное удлинение после разрыва4 %
- Твердость по Шору А76-86 ед.
- Сопротивление раздиру, не менее30 Н/мм
- Износостойкость 40 мм
Маслобензостойкость-высокая
Температура эксплуатацииград.С-30 +80
Водостойкость-удовл.
Фторопласт - полимерный материал, получаемый
химическим путём. Фторопласт содержит атомы фтора, благодаря чему имеет высокую
химическую стойкость. Плохо растворяется или не растворяется во многих
органических растворителях, не растворим в воде и не смачивается ею.
Фторопласты характеризуются широким диапазоном
механических свойств, хорошими диэлектрическими свойствами, высокой электрической
прочностью, низким коэффициентом трения, низкими значениями износа; стойки к
действию различных агрессивных сред при комнатной и повышенной температуре,
атмосферо-, коррозионно- и радиационностойки, слабо газопроницаемы, не горючи
или самозатухают при возгорании. Очень высокая нагревостойкость (до 300°С).
Материал обладает холодной текучестью. Ципрофлоксаци́н
(лат. Ciprofloxacinum, англ. Ciprofloxacin) - C17H18FN3O3. Лекарственное
средство, антибактериальный препарат из группы фторхинолонов II поколения.
Бледный, слегка желтоватого оттенка кристаллический порошок, растворим в 0,1 н.
растворе соляной кислоты, практически нерастворим в воде и этаноле.

Рисунок 1- формула Ципрофлоксацин
(Ciprofloxacinum)
Химическое соединение:
-циклопропил-6-фтор-4-оксо-7-пиперазин-1-ил-хинолин-3-карбоновая
кислота.
ПГМГ-гидрохлорид или полигексаметиленгуанидин
гидрохлорид - катионный полиэлектролит, обладающий уникальным сочетанием
физико-химических и биоцидных свойств, позволяющий этому полимеру применятся
практически во всех сферах народного хозяйства. Его структурная формула:
(C7H16N3Cl)n, где n=4-50, молекулярный вес: 700-10000 а.е.м. Не имеет цвета и
запаха (некоторые не очень качественные образцы продукта имеют запах аммиака), пожаробезопасен,
взрывобезопасен, полностью растворим в воде, растворим в спирте, не теряет
своих свойств при отрицательных температурах, не разлагается и сохраняет свои
физико-химические и биоцидные свойства до температуры +120 С°. pH 1%-го водного
раствора 7-10,5. Срок годности 20%-го водного раствора - не менее 5 лет,
100%-го концентрата - не менее 7 лет.
"Серебро обладает более
высоким антимикробным эффектом, чем ципрофлоксаци́н,
пенициллин, биомицин и другие антибиотики, и оказывает губительное действие на
антибиотикоустойчивые штаммы бактерий" [71]. Авторы [72], разрабатывая
новую антимикробную серебросодержащую композицию, приводят любопытные данные о
сравнительной бактерицидной активности традиционных антибиотиков и серебра (в
таблице через дробь указано значение минимальной ингибирующей
(бактериостатической) концентрации (МИК) мг/л / минимальной бактерицидной
концентрации (МБК), мг/л лекарственных веществ). Из таблицы видно, что если
определенные антибиотики более эффективны в отношении определенных
микроорганизмов,
то общее неспецифическое антимикробное действие выше у серебра.
В
таблице 1 приведена бактерицидная активность традиционных антибиотиков и
серебра.
Таблица 1- Сравнительная
бактерицидная активность традиционных антибиотиков и серебра, МИК/МБК, мг/л
|
Организм
|
Теtracycline
|
Ofloxacin
|
Рenicillin
|
Сefaperazone
|
Erythromycin
|
Серебро
|
|
S. pyogenes
|
0.625/>5
|
1.25/2.5
|
>5.0
|
0.313/1.25
|
0.003/0.019
|
2.5/5.0
|
|
S. mutans
|
0.625/>5
|
2.5/>5.0
|
0.521/>5
|
1.25/>5
|
0.009/0.019
|
2.5/10.0
|
|
S. gordonil
|
0.156/0.625
|
2.5/5.0
|
0.009/0.039
|
1.25/1.25
|
0.005/0.019
|
2:5/10.0
|
|
S.pnuemo-niae
|
0.078/0.625
|
2.5/2.5
|
0.019/0.019
|
0.313/0.313
|
0.002/0.004
|
2.5/2.5
|
|
S. faecalis
|
0.313/>5
|
1.25/5.0
|
5.0/>5.0
|
>5.0
|
0.009/1.25
|
10.0/10.0
|
|
S. aureus
|
0.313/>5
|
0.417/ 0.625
|
2.5/>5.0
|
5.0/5.0
|
0.039/>5.0
|
5.0/5.0
|
|
Р.
aeruginosa
|
0.078/5
|
0.156/ 0.313
|
0.13/>5.0
|
2.5/5.0
|
2.5/>5.0
|
1.67/5
|
|
е. сoli
|
1.67/>5
|
0.104/ 0.156
|
>5.0
|
0.625/>5.0
|
5.0/>5.0
|
2.5/2.5
|
|
Е.aerogenes
|
>5
|
0.078/ 0.156
|
>5.0
|
2.92/>5.0
|
>5.0
|
2.5/2.5
|
|
Е.
с1оасае
|
1.67/>5
|
0.156/ 0.156
|
>5.0
|
>5.0
|
>5.0
|
2.5/5.0
|
|
S. tiphimurium
|
1.25/>5
|
0.078/ 0.156
|
>5.0
|
1.25/2.5
|
5.0/>5.0
|
2.5/5.0
|
|
S. Arizona
|
0.625/ >5
|
0.078/ 0.078
|
>5.0
|
0.833/>5.0
|
4.17/>5.0
|
2.5/5.0
|
|
S.boydii
|
1.25/>5
|
0.078/ 0.156
|
>5.0
|
0.625/0.625
|
5.0/>5.0
|
1.25/
1.25
|
|
К.
рпеитоniae
|
2.5/>5
|
0.417/ 0.625
|
>5.0
|
>5.0
|
>5.0
|
2.5/2.5
|
|
К.
охуtоса
|
1.25/>5
|
0.104/ 0.156
|
>5.0
|
1.25/>5.0
|
>5.0
|
1.2/
1.25
|
2.2 Методика осаждения покрытия из активной
газовой фазы
Процесс нанесения вакуумных
покрытий предполагает реализацию следующих основных стадий:
образование газовой фазы
(генерация паров, летучих продуктов);
- перенос атомов, частиц
вещества от источника газовой фазы до покрываемой поверхности;
взаимодействие частиц газовой
фазы с поверхностью и образование покрытия.
Все известные методы нанесения
покрытий отличаются способами генерации газовой фазы, режимами и условиями
массопереноса и пленкообразования.
В качестве материала подложек
использовали пленки металлизированного лавсана и отрезки стерильной марли (для
микробиологических исследований).
Композиционные покрытия
формировали в вакууме из активной газовой фазы, образованной продуктами
электронно-лучевого диспергирования серебросодержащего соединения. Процесс
осаждения покрытий производился при начальном давлении остаточных газов в
вакуумной камере » 5.10-3
Па с помощью устройства, схема которого представлена на рисунок- 2.

В качестве источника электронов
использовался электронно-лучевой прожектор с катодом прямого накала,
позволяющий формировать пучки с
плотностью тока I
= 50÷500
А/м2, энергией частиц E
= 0,1÷2,5
кэВ, площадью пятна S
= (1÷5).10-4
м2 с возможностью поворота луча на 180°.
Для поворота луча применялось постоянное магнитное поле. Поток электронов
направлялся на тигель с диспергируемым материалом. Расстояние между тиглем и
подложкодержателем составляло 20 см.
Формирование покрытия сопровождалось лазерным
ассистированием с длинно волны 532 нм (с целью формирование потока частиц с
заданным распределением кластеров по размеру). Нанесение покрытий проводилось в
ГГУ им Ф. Скорины. Толщины наносимых покрытий, контролировалась кварцевым
измерителем толщины.
В качестве подложек выступали чашки петри (для
микробиологических исследований) и катриджы водяного фильтра из ПП-волокна.
Формировались поркытия толщиной 5, 20, 50 нм (1, 2, 3 соотвественно).
Геометрические характеристики исследуемого
образца представлены на рисунке 3.

Рисунок 3- исследуемые полипропиленовые (ПП)
волокна без покрытия и с серебросодержащим покрытием.
Полипропиленовое ( ПП ) волокно - синтетическое
волокно , формуемое из расплава полипропилена.
Отличительные свойства ПП волокон .
— Исключительной особенностью этих волокон
является их очень низкая плотность 0,91-0,92 г/см3.Это самые легкие из всех
известных волокон. Гигроскопичность нитей практически равна нулю. Поэтому
изделия из них не тонут в воде.
- ПП волокно по эластичности, устойчивости к
двойным изгибам, как правило, превосходит полиамидные волокна , но уступает им
по стойкости к истиранию.
- Обладает хорошими теплоизоляционными
свойствами, имеет высокую стойкость к действию
кислот, щелочей, органических растворителей.
ПП волокно имеет высокое сопротивление к
бактериям, насекомым и плесени.
Недостатки - довольно низкая термостойкость
(110-115С), поэтому изделия с использованием ПП волокон не должны подвергаться
действию высоких температур. Термо- и светостойкость в значительной мере
определяются эффективностью вводимых стабилизаторов.
Значительная часть ПП волокон выпускается
физически и химически модифицированными, с существенно повышенными
эксплуатационными свойствами.
Лазерная технология нанесения покрытий имеет
следующие основные преимущества:
— Нет необходимости в
применении в устройствах для испарения источников высоких напряжений.
Реализуются достаточно чистые
условия нанесения покрытий, так как осуществляется нагрев только мишени.
Возможность достижения в потоке
высокой плотности энергии - 108 ...109 Вт/см2и,
как следствие этого, получение покрытий из самых тугоплавких материалов и
диэлектриков.
— Высокая мгновенная
скорость напыления (103... 105нм/с), что положительно
сказывается на качестве образующихся слоев; покрытие является более однородным,
сплошным, имеет высокодисперсную структуру.
Высокая стабильность процесса
испарения, так как отсутствуют жесткие требования к степени вакуума при работе
лазерных испарительных систем.
Высокая производительность и
технологичность.
Сканирование лазерного луча по
поверхности позволяет равномерно испарять мишень и получать однородные
покрытия.
Исследуемых тигли типа:
- ( Cipr ) Ципрофлоксаци́н;
(PU+AgAC) полиуритан и серебросодержащее
органическое соединение;
(PGhlorid+PU)
ПГМГ-гидрохлорид или полигексаметиленгуанидин гидрохлорид и полиуритан;
(AgAc) серебросодержащее органическое
соединение;
(Cipr+PU) Ципрофлоксаци́н
и полиуритан;
(PG hlorid) ПГМГ-гидрохлорид или
полигексаметиленгуанидин гидрохлорид и полиуритан;
(PU)
полиуритан.
2.3 Методика микроскопических исследований
Просвечивающая электронная микроскопия - метод
анализа внутренней микроструктуры и размера ультратонких, прозрачных для
ускоренных электронов, образцов тоньше 100 нм, который осуществляется
облучением исследуемой области потоком ускоренных электронов. Изображение,
полученное таким образом, является как бы "тенью" образца,
увеличенная копия которой проецируется на флуоресцентный экран или фотопленку.
По этому изображению можно судить о форме и размерах частиц, из которых состоит
образец. Благодаря тому, что ускоренные электроны взаимодействуют с
электронными оболочками атомов изучаемого вещества, с помощью электронного
микроскопа получают дифракционную картину от упорядоченной структуры атомов, из
которой можно извлечь информацию о кристаллических фазах. Современные
электронные микроскопы высокого разрешения, обладающие очень точной системой
фокусировки, позволяют визуализировать картину распределения электронной плотности
в образце, то есть практически "увидеть" ряды отдельных атомов [74].

Рисунок 4- Электронный
микроскоп JEM-2100
В таблице 2 представлены технологические
характеристики Электронного микроскопа JEM-2100
Таблица 2- Технологические характеристики
Электронного микроскопа JEM-2100
|
Характеристика
|
Значение
|
|
Ускоряющее
напряжение
|
от
80кВ до 200 кВ
|
|
Разрешение
по точкам
|
0.19
нм
|
|
Разрешение
по линиям
|
0.14
нм
|
|
Электронная
пушка
|
LaB6
|
|
Увеличение
|
X50
- x1,500,000
|
В исследованиях новых материалов и нанообъектов
важную роль играет просвечивающая электронная микроскопия. Электронный
микроскоп JEM-2100 сочетает высокие электронно-оптические параметры,
разнообразные методические возможности получения и вывода информации, эффективность
и удобство работы. Микроскоп оборудован LaB6 катодом повышенной
яркости, цифровым сканирующим устройством, устройством изменения угла
сходимости электронного пучка для выполнения исследований методом сходящегося
пучка, гониометром с пьезоконтролем положения объекта на атомном уровне.
Конструкция микроскопа обладает повышенной виброустойчивостью. Вывод
изображений осуществляется как на флуоресцентный экран, так и на монитор с
помощью CCD камеры высокого разрешения и с увеличенным полем зрения. В управлении
многофункциональной электронно-оптической системой прибора и вывода изображения
используется операционная система WINDOWS [75].
Виды выполняемых анализов:
Светлопольные и темнопольные изображения тонких
объектов "на просвет";
Изображения прямого разрешения кристаллической
решетки;
Изображения в растровом режиме;
Изображения в сходящемся пучке.
Электронная пушка высокой яркости
Катод из гексаборида лантана (LaB6)
генерирует пучок электронов высокой интенсивности и стабильности. Такой тип
катода эффективен для высокочувствительного анализа областей от микро- до нано
размеров, а также для получения изображений высокого разрешения. Когда вы
Удобный выбор оптимального ускоряющего напряжения позволяет изучать образцы,
чувствительные к воздействию пучка, такие как углеродные нанотрубки, полимерные
материалы и т.п.
Пьезо-привод гониометрического держателя
Гониометрический держатель обновлённой
конструкции снабжен пьезоприводом и осуществляет позиционирование образца с
высокой точностью в широком диапазоне увеличений.
Обновлённая конструкция базового блока
JEM-2100
сконструирован на основе улучшенного основания базового блока и новой системы
пассивной воздушной амортизации, серьёзно улучшивших защищённость микроскопа от
микро вибраций [75].
.4 Микробиологические исследования
опытных одноразовых стерильных полистироловых
чашек Петри диаметром 90 мм с покрытиями разных типов, 1 контрольная чашка
Петри без покрытия (контроль роста)
Рисунок 5- Контроль роста бактерий типа золотистый
стафилакокк - S.aureusATCC
25923, кишечной палочки - E.coli ATCC 25922,
кандидоз (молочница) - Candida albicans
ATCC 90028.
Тест-культуры:
S.aureusATCC
25923- золотистый стафилакокк;
E.coli ATCC 25922
- кишечная палочка;
Candida albicans ATCC 90028
- кандидоз.
В чашки Петри пипеткой вносили по 20 мл
расплавленного и остуженного до 50°Сагара Мюллера-Хинтона и выдерживали на
горизонтальной поверхности при комнатной температуре до застывания среды. 30
минут подсушивали чашки Петри в термостате при 37°C.
Стерильными тампонами на сектора чашек Петри
наносили отдельными пятнами суспензии тест-культур микроорганизмов (оптическая
плотность суспензии - 0,5 МакФарланд).
Инкубировали посевы 18 часов 37°C.
Результаты учитывали визуально по наличию (+) или отсутствию (-) роста в местах
нанесения суспензий тест-культур.
.5 Тест на биосовместимость
На рисунке 6 изображен прибор для проверки на
биосовместимость.

Два стеклянных прозрачных сосуда в них находятся
пластиковые цилиндры с трубками через которые подключены к компрессору. В одном
из пластиковых цилиндров находится ПП-волокно с Серебросодержащим покрытием, в
другом ПП-волокно без покрытия. Улитки (ампулярии) составляющая часть
эксперимента.
Моделировался фильтр работающий на замкнутый
объем воды.
В сосуд, наполненный водой, помещаем живой
организм (ампулярии), имеющие наивысшую чувствительность к тяжелым металлам
среди беспозвоночных. Полипропиленовый картридж помещался в корпус фильтра
подключенного к компрессору.
Одновременно ежедневно контролировалась яркость
фильтрующего элемента бес покрытия и с серебросодержащим антибактериальным
покрытием с помощью фотоаппарата.
После получения экспериментальных данных
необходимо произвести их обработку, для этого:
Из фотоснимка вырезать максимально возможный
одинаковый размер (100х120 Пик);
Сохранить в BNP
файле с 24-ех битной палитрой;
Построить график зависимости яркость от даты
фотоснимка;
Проанализировать данные.
3. Результаты экспериментальных исследований
3.1 Анализ Электронно-лучевого диспергирования с
применением различной природы матриц
При проведении испытания на определение толщины
покрытия и рабочего давления были построены кривые зависимости толщины от
времени и давления от времени (рисунок 7) для следующих образцов: (PU)
полиуретан; (Cipr)
ципрофлоксацин; (PGhlorid)
ПГМГ-гидрохлорид или полигексаметиленгуанидин гидрохлорид; (Cipr+PU) полиуретан
и антибиотик "ципрофлоксацин"; (PG hlorid+PU) полиуретан и
ПГМГ-гидрохлорид; (PU+AgAC)полиуретан и серебросодержащее органическое
соединения; (AgAC) серебросодержащее органическое соединения
Электронно-лучевое диспергирование с применением
полимерной матрицы полиуретана (рисунок 7- а). Установлено, что в одинаковый
период времени от 0 до 8 секунд происходит индукционный период, затем идет рост
толщины покрытия и давления соответственно. Толщина покрытия PU
и давления изменяются с течением времени. Достигнув 70 секунд толщина покрытия PU
и давления приобрели линейный характер.
На рисунке 7- б представлена зависимость толщины
от времени и давления от времени антибиотика ципрофлоксацина (Cipr).
Индукционный период длиться 6 секунд (от 0 до 6), а затем такие составляющие
как давление и толщина покрытия начинают расти и рост их протекает определенное
время равное 17 секунд. Достигнув максимального значения толщины (Cipr)
приобретает линейный характер и не изменяется со временем. После индукционного
периода начинается рост давления, но длительность его составило лишь 17 секунд,
затем давления снижается и достигнув по шкале отметки 10 приобрело не
изменяющийся вид.
Рассмотрим рисунок 7-в. В виде исходного
материала применяется ПГМГ-гидрохлорид или полигексаметиленгуанидин
гидрохлорид. Выявлено, что в одинаковый период времени от 0 до 12
секундпротикает индукционный период, затем наблюдается рост давления в течении
60 секунд, затем сопутствует его спад до 0 по шкале. Ярко выражен стремительный
рост толщины покрытия (PGhlorid).
Время роста толщины покрытия так же равно 60 секунд, затем рост замедляется и
прекращает изменяться со временем.
Электронно-лучевое диспергирование с применением
полимерной матрицы полиуретана и антибиотика "ципрофлоксацин"
(Cipr+PU) рисунок 7-г. Установлено, что в период времени от 0 до 5 секунд
происходит индукционный
период, затем стремительно увеличивается толщина покрытия (Cipr+PU) и давление.
За период времени равный 80 секунд толщина прекращает свой рост и с течением
времени имеет линейный характер. Давление в течении времени равное 80 секунд
так же изменяется, при этом преобладает колебательный характер, но со временем
переходит в линейный.
На рисунке 7-д рассмотрим электронно-лучевое
диспергирование с применением полимерной матрицы полиуретана и ПГМГ-гидрохлорид
или полигексаметиленгуанидин гидрохлорид. Выявлено, что в одинаковый период
времени от 0 до 27 секунд протикает индукционный период, затем наблюдается рост
толщины покрытия PG hlorid+PU и скачкообразное со знаком плюс изменения
давления. В течении 215 минут протекает изменения толщины покрытия PG hlorid+PU
и давления.
На рисунке 7-е представлен график зависимости
толщины от времени и давления от времени полимерной матрицы полиуретана и серебросодержащего
соединения (PU+AgAC). Отметим , что индукционного периода в данном случае не
наблюдается, что говорит о том, что покрытия изначально начало расти, давление
так же стремительно увеличивается, но скачкообразно. В течении 350 секунд
наблюдается изменения в толщине покрытия PU+AgAC и в давлении.
Из полученных результатов, изображенных на
рисунке 7- ж ((AgAC) серебросодержащее соединения) следует, что в одинаковый
период времени длительно от 0 до 90 протекает индукционный период, затем
активное газовое выделение сопровождающееся ростом давления и толщины покрытия.
Проанализировав все исходные материалы, можно
обратить внимания на то что, покрытия на рисунке 7- а ((PU)
полиуретан) имеет самую маленькую толщину, а покрытия на рисунке 7 е-ж
(е-(PU+AgAC)полиуретан и серебросодержащее соединения; ж- (AgAC)
серебросодержащее соединения) имеет наибольшую толщину до 250 Гц.

Рисунок 7- график зависимости толщины от времени
и давления от времени: а- (PU)
полиуретан; б- (Cipr)
ципрофлоксацин; в- (PGhlorid)
ПГМГ-гидрохлорид или полигексаметиленгуанидин гидрохлорид; г- (Cipr+PU)
полиуретан и антибиотик "ципрофлоксацин"; д- (PG hlorid+PU)
полиуретан и ПГМГ-гидрохлорид; е-(PU+AgAC)полиуретан и серебросодержащее
соединения; ж- (AgAC) серебросодержащее соединения.
3.2 Морфология наночастиц серебра
Синтезированные на пористые материалы покрытия,
содержащие наночастицы серебра исследовались методами просвечивающей
электронной микроскопии. Анализ данных морфологии наночастиц серебра позволил
установить, что диаметр сформированных частиц не превышал 50 нм, а наиболее
вероятный размер составлял 16 нм.
Анализ морфологии поверхности представлен на
рисунке 8-11.

3.3 Анализ микробиологических исследований
В ходе биологических исследований были изучены
бактерии типа: золотистый стафилококк - S.a., кишечной палочки -E.c., Кандидоз
(молочница) - C.a.
На рисунке 12.1 изображен контроль роста
бактерий типа золотистый стафилококк - S.a.,
кишечной палочки -E.c.,
Кандидоз (молочница) - C.a.
На рисунке 12.2 и 12.3 изображено резистивное
нанесение Ag толщина 1 и толщины 2 соответственно. В случае резистивного
нанесение серебра, установлено, что при минимальной толщине покрытий 1 до
сплошного зеркального (покрытие 12- 2) подавление роста бактерии типа S.a.,
E.c.,
C.a
не наблюдалось. Покрытия не обладили выраженными антибактериальными свойствами.
На рисунке 12.4, 12.5, 12.6 изображено
плазмохимическое нанесение Ag толщина 1, 2 и 3 соответственно. Установлено, что
в случае плазмохимического нанесения серебра, толщина 1 - это минимальная
концентрация, а толщина 3, максимальная концентрация серебра. Выявлено, что
толщина 1 (рисунок 12-4) обладает бактериостатическими свойствами (уменьшение
площади колоний роста ) к бактериям типа: кишечной палочки -E.c.,
Кандидоз (молочница) - C.a.
и обладает бактериоцидным свойствам (отсутсвие колоний роста ) к бактериям
типа: золотистый стафилококк - S.a..
На рисунке 12.5 находится плазмохимическое нанесение Ag толщины 2. Установлено,
что толщина 2 обладает бактериостатическими свойствами к бактериям типа:
золотистый стафилококк - S.a.,
кишечной палочки -E.c..
Следующим объектом исследования является толщина 3 (рисунок 12.6). Толщина 3
обладает явно выраженным бактериоцдным свойствам (отсутсвие колоний роста ) к
бактериям типа: золотистый стафилококк - S.a.,
кишечной палочки -E.c.,
Кандидоз (молочница) - C.a.
Бактерии не размножаются и не развиваются при толщине 3.
Согласно полученным данным по всем экспериментам
выявили, что покрытие плазмохимическим нанесением Ag толщиной 3, по сравнению с
покрытием плазмохимическим нанесением Ag толщиной 1 и 2, а так же с покрытием
резистивное нанесение Ag толщина 1 и толщины 2, является наиболее эффективным
антибактериальным покрытием. Плазмохимическим нанесением Ag толщиной 3 не
позволяет расти и размножаться бактериям типа золотистый стафилококк - S.a.,
кишечной палочки -E.c., Кандидоз (молочница) - C.a.
На рисунке 12 представлены данные биологического
исследования антибактериального серебросодержащего покрытия.

Рисунок 12- Биологические исследования,
1-
контроль роста бактерий типа золотистый стафилококк - S.a.,
кишечной палочки -E.c.,
Кандидоз (молочница) - C.a.
2, 3 - резистивное нанесение Ag толщина 1 и толщины 2 соответственно; 4,5,6-
плазмохимическое нанесение Ag толщина 1, 2 и 3 соответственно.
.4 Анализ тестов фильтрующих элементов на
биосовместимость
Тест с покрытием №1 длился с 25 февраля по 17
марта.
ПП-волокно с покрытием под номером 1
(минимальной толщиной антибактериального серебросодержащего органического
соединения) оказалось биосовместимо с ампуляриями, но данные яркости
фильтрующих элементов с покрытием 1 существенных различий в яркости, с исходным
ПП-волокном без покрытия, не выявили.
На рисунке 13 представлен анализ некоторых
характерных фото с покрытием №1 на 5-ый день испытания.

Рисунок 13- Характерное фото покрытия №1 на 5-ый
день.
На рисунке 14 представлен анализ некоторых
характерных фото с покрытием №1 на 20-ый день испытания.

Рисунок 14- Характерное фото покрытия №1 на
20-ый день.
Тест с покрытием №2 длился 25 суток (с
11.02.2011 по 5.05.2011). После получения фотоснимоков, числом равным 25 штук,
провели обработку данных. На рисунке 13 представлены данные.
В случаи покрытия ПП-волокна под номером 2
выявлено, что ПП-волокно с покрытием серебросодержащего органического
соединения, во-первых биосовместимы с живыми организмами (ампуляриями).
Во-вторых, обладает большей яркостью с течением времени, чем ПП-волокно без
покрытия. Данных яркости фильтрующих элементов показывающий способность
покрытия к подавлению роста бактерий и грибов позволил установить, что образец
2 на первый день обладает меньшей яркостью в 0,7 раз чем ПП-волокно без
покрытия. На пятый день в 1.1 раза большей яркостью, чем ПП-волокно без
покрытия. Из-за роста, на фильтрующем элементе, бактерии и грибков, в конце
отличается в 4 раза.
Следовательно, покрытие 2 является
биосовместимым и антибактериальным покрытием.
На рисунке 15 представлен анализ некоторых
характерных фото с покрытием №2 на 5-ый день испытания.

Рисунок 15- Характерное фото покрытия №2 на 5-ый
день.
На рисунке 16 представлен анализ некоторых
характерных фото с покрытием №2 на 20-ый день испытания.

Рисунок 16- Характерное фото покрытия №2 на
20-ый день.
Тест с покрытием №3 длился с 18 по 22 марта.
По результатам третьего теста на
биосовместимось, в роли исследуемого материала выступало ПП-волокно с
максимальной толщиной под номером 3, выявлено, что покрытие не биосовместимо.
На
рисунке 17 представлен анализ некоторых характерных фото с покрытием №3 на 2-ой
день испытания.

Рисунок 17- Характерное фото покрытия №3 на 2-ой
день.
В таблице 4 представлен результат данных по
тесту на биосовместимость.
Таблица 4- Результат данных
|
Покрытие
|
Толщина,
нм
|
Биосовместимость
|
|
№1
|
5
|
Есть
|
|
№2
|
20
|
Есть
|
|
№3
|
50
|
Нет
|
Следовательно, анализ тестов фильтрующих
элементов на биосовместимость показал что образец 1, 2 обладают
биосовместимостью к (ампуляриями), в то время как образец 3 не обладают
биосовместимость к (ампуляриями). Данные яркости фильтрующих элементов без
покрытия и с покрытием 1 существенных различий в яркости не выявили.
По полученным результатам построим график
зависимости яркости ПП волокна без покрытия и ПП-волокна с покрытием под № 2

Рисунок 18- График зависимости яркости
ПП-волокна без покрытия и ПП-волокна с покрытием 20нм.
Расчет максимальных ингибирующих концентраций
показал, что синтезированные наночастицы серебра обладают бактерицидных свойствами
к бактериям устойчивым к действию антибиотиков. К тому же установлено что
максимальные ингибирующие концентрации не превышают в питьевой воде - 50 мкг/л
В таблице 5 приведены
максимальные ингибирующие концентрации наночастиц серебра для референсных культур
микроорганизмов.
Таблица 5- максимальные ингибирующие
концентрации наночастиц серебра для референсных культур микроорганизмов.
|
ОРГАНИЗМ
|
МИК,
мкг/мл
|
|
S.aureus
ATCC 25923
|
1
|
|
S.aureus
ATCC 35591 (MRSA)
|
2
|
|
E.coli
ATCC 25922
|
1
|
|
E.coli ESBL CTX M-3
|
0,5
|
|
K.pneumoniae
ATCC 13883
|
2
|
|
K.pneumoniae ATCC 700603 (ESBL
SHV)
|
1
|
|
P.aeruginosa
ATCC 27853
|
2
|
|
P.aeruginosa
257 MBL VIM
|
4
|
|
S.Typhimurium
ATCC 13311
|
2
|
|
S.sonnei
ATCC 29930
|
2
|
4. Технологическая инструкция
Данный проект комплекта
документов разработан для использования в ремонтных мастерских, имеющих
специализированные участки и оборудование для вакуумной активации
серебросодержащего органического соединения в плазме тлеющего разряда.
1. Общие сведения.
1.1. Предлагаемый метод
модификации заключается в активации серебросодержащего покрытия, повышающего
антибактериальные свойства картриджа водяного фильтра. Активацию проводят в
плазме тлеющего разряда в вакууме.
.2 Для модификации картриджа
водяного фильтра используется установка УВН-71 М, оборудованной системой
откачки и системой управления.
. Указания мер
безопасности
.1 Общие указания
.1.1 Модификация
модифицирования для картриджа водяного фильтра производится на лабораторной
установке УВН-71 М. К работе на установке
допускаются лица, прошедшие медицинский осмотр, местный инструктаж по
безопасности труда, изучившие техническое описание вакуумной установки и
ультразвукового генератора, инструкцию по эксплуатации, инструкцию по технике
безопасности при работе на данном оборудовании, изучившие данный комплект документов,
прошедшие обучение технологии модификации и имеющие удостоверение на право
работы на электроустановках с напряжением до 1000 В с квалификацией по
электробезопасности не ниже 3 группы.
.1.2 На участке может работать
смена не менее чем из двух человек, имеющих квалификационную группу по технике
безопасности не ниже третьей.
.1.3 Ремонтные и наладочные
работы разрешается проводить бригаде, состоящей не менее чем из двух человек с
разрешения начальника участка, обеспечивающего все организационные и технические
мероприятия для безопасной работы.
2.1.4 В помещении
технологического участка уборка должна производиться влажным способом при
полном снятии напряжения и в присутствии кого-либо из персонала участка.
.2 Правила электробезопасности
.2.1 Блок вакуумный и стойка
питания и управления должны быть заземлены голым медным проводом площадью
поперечного сечения не менее 6 мм2.
2.2.2 Запрещается работать при снятых обшивках,
кожухах, открытых дверях вакуумной установки.
2.2.3 Запрещается оставлять без
наблюдения вакуумную установку, находящиеся под напряжением.
.3 Правила термобезопасности
.3.1 Соблюдать осторожность при
работе с нагретыми частями установки во избежание ожогов (нагреватель
паромасляного насоса, рабочий стол, обрабатываемые изделия).
.4 Правила пожаробезопасности
.4.1 Легко воспламеняющиеся
жидкости (ЛВЖ) должны храниться в небьющейся, герметически закрытой посуде и
таре.
.4.2 Запас ЛВЖ на рабочем месте
не должен превышать потребности на одну смену.
.4.3 Обтирочный материал должен
храниться в специальных металлических ящиках с закрывающимися крышками.
Работающим на участке
запрещается:
работать при отсутствии
проверенных средств защиты пожаротушения;
производить работы по
частичному или полному демонтажу вакуумной системы при выключенной вентиляции.
3. Технические
требования к очистным картриджам водяного фильтра.
.1 Картриджам водяного фильтра
должны соответствовать техническим требованиям на их изготовление и должны быть
приняты ОТК.
4 Порядок
работы комплекса оборудования для модифицирования очистного картриджа водяного
типа
.1 Подготовительная очистка
.1.1 Произвести очистку
вакуумной камеры от металлической пыли пылесосом. Допускается очистку
производить щеткой.
.1.2 Протереть бязью, смоченной
в спирте, узлы вакуумной камеры. Протирку внутренней поверхности рабочей
камеры, съемных защитных устройств, испарителей, стола, затвора производить не
реже одного раза в неделю. Протирку уплотнительных резиновых прокладок,
защитных стекол и приспособлений, в которых обрабатываются детали, производить перед
каждой загрузкой.
4.1.3 Вращение с частотой ν=20об/мин
4.2 Обработка в плазме тлеющего
разряда на установке УВН - 71М
.2.1 Откачать камеру до
давления -×5 Па. Включить
источник питания и зажечь разряд. Установить ток 80 mА
и дождаться стабильного горения разряда. Открыть заслонку и производить
обработку с -ПП- волокном..
.2.2 Выключить источник
питания.
.3 Загрузка
.3.1 Установить картридж в
технологической оснастке на рабочий стол вакуумной камеры. При установке
пользоваться чистыми хлопчатобумажными перчатками или пинцетом.
.3.2 Проверить расположение
детали в вакуумной камере. Соприкосновение деталей со стенками камеры не
допускается.
.3.3 Закрыть дверку вакуумной
камеры.
.4. Нанесение
антибактериального серебросодержащего покрытия.
.4.1 Покрытие серебросодержащего
органического соединения наносят методом осаждения из активной газовой фазы,
формируемой электронно-лучевым диспергированием исходного полимера в вакууме.
Для модификации серебросодержащих
покрытий используется лабораторная установка нанесения покрытий УВН-71 М,
оборудованную блоком электронно-лучевого диспергирования.
.4.2 Установка вакуумная
состоит из следующих основных частей:
стойка питания и управления;
стойка питания дуговых
испарителей;
стойка питания
электронно-лучевого диспергирования;
блок вакуумный.
.5. Вакуумирование
.6.1. Открыть вентиль подачи
холодной воды, убедиться в наличии воды в системе охлаждения установки. Открыть
вентили подачи горячей воды и сжатого воздуха.
.5.2. Подать на установку
напряжение питания. Включить форвакуумный агрегат. Открыть форвакуумный клапан.
Включить нагрев диффузионного насоса.
.5.3. В процессе работы
давление в диффузионном насосе и в вакуумной камере контролировать по прибору
ВИТ-2.
.5.4. После достижения в
диффузионном насосе вакуума 5·10-2 Па
закрыть форвакуумный клапан;
открыть байпасный клапан;
включить подогрев камеры;
отвакуумировать вакуумную
камеру до давления 5 Па.
.5.5. После достижения в
вакуумной камере давления 5 Па:
закрыть байпасный клапан;
открыть форвакуумный клапан;
открыть высоковакуумный затвор;
включить охлаждение камеры;
- отвакуумировать вакуумную камеру до давления 5
10-3 Па.
4.6 Нанесение антибактериальное
серебросодержащее покрытие.
.6.1 Включить блок питания
диспергатора, установив ток накала вольфрамовой нити ~6А. Подать ускоряющий
потенциал 1200 В. Контролировать попадание луча в кювету с серебросодержащим
органическим соединением. Давление в камере 0.5 - 0.2·10-2 Па.
Толщина покрытия 5 нм, 20 нм, 50 нм.
.6.2 Лазерное ассистирование,
532нм.
Энергия накачки лампы 35Дж
.6.3 Установить мощность 0.27 Вт.
4.6.4
Контроль толщины покрытия., кварцевым измерителем
толщины.
.6.5 Запустить прибор "Solar"
4.6.6
Отключить ускоряющий потенциал, убрать ток накала, выключить блок питания
диспергатора. Выждать 10 минут и закрыть высоковакуумный затвор.
.7 Выгрузка
.7.1 Напустить в камеру воздух.
Открыть камеру.
.7.2 Выгрузить из вакуумной
камеры очистной картридж водяного фильтра и установить его на подставке.
Пользоваться пинцетом.
.8. Контроль качества
обработанных щитов
.8.1. Произвести визуальный
осмотр. На рабочих поверхностях не допускается отслаивание покрытия. Проверку
производить с помощью 4-х кратной лупы.

5. Расчёт экономической эффективности от
оптимизации технологии обработки антибактериальных серебросодержащих покрытий
Антибактериальное серебросодержащее покрытие
дорогое, но при этом является эффективным антибактериальным средством. Именно
поэтому необходимо знать какой из технологических процессов нанесения
серебросодержащего покрытия толщиной 2 или 3 дает возможность перейти на выпуск
более экономичным и рациональным процессом.
Себестоимость единицы продукции
 (1)
(1)
где См - затраты на материалы, руб.;
Сз - затраты на заработную плату,
руб.;
Сэ - затраты на энергоресурсы, руб.;
Са - амортизационные отчисления по
оборудованию, руб.;
Ср - затраты на текущий ремонт
оборудования, руб;
Сп - затраты на отопление, освещение,
уборку, ремонт и амортизацию помещения.
Затраты на материалы
для одного изделия с антибактериальным серебросодержащим покрытием
 (2)
(2)
m - масса одного изделия;
Цст-
цена 1 кг материала; k1
-
коэффициент, учитывающий транспортно-заготовительные расходы на приобретение
материалов.
Для толщины 2

где m1=1,29 гр.; Цст=25000000
руб.; k1=1,05.
Для толщины 3

где m2=2,03 гр.; Цст=25000000
руб.; k1=1,05.
Заработная плата рабочего

где t0
-
время проведения технологического процесса, t01=0,028ч.,
t02=0,083ч;
 - часовая тарифная
ставка термиста 4-го разряда, руб.;з - коэффициент, учитывающий
доплаты к заработной плате и отчисления на
социальное страхование;o
-
коэффициент основного времени, ko=0,55.
- часовая тарифная
ставка термиста 4-го разряда, руб.;з - коэффициент, учитывающий
доплаты к заработной плате и отчисления на
социальное страхование;o
-
коэффициент основного времени, ko=0,55.
Доплаты к тарифной заработной плате:
- за качественную работу - 50-95% от r,
принимаем 75%;
- за выслугу лет - 5-35% от r, принимаем 20%;
за вредность - 5-25% от r, принимаем 15%.
Тогда, 
Часовая тарифная ставка рабочего 4-го разряда

где r1 - тарифная ставка термиста
первого разряда, r1 = 200000 руб.;
 - тарифный
коэффициент для 4-го разряда,
- тарифный
коэффициент для 4-го разряда,  =1,2;м-
месячный фонд времени рабочего, определяется по формуле
=1,2;м-
месячный фонд времени рабочего, определяется по формуле

где  -
номинальный годовой фонд времени рабочего,
-
номинальный годовой фонд времени рабочего,  =
2050 ч.
=
2050 ч.

Для толщины 2

Для толщины 3

Затраты на электроэнергию

где W - расход технологической электроэнергии,
W=40 кВт·ч;
Цэ - цена 1 кВт·ч
электроэнергии, Цэ =180 руб.

Амортизационные отчисления по оборудованию

где С0 - стоимость оборудования, С0=200000000
руб.;
А0 - норма годовых амортизационных
отчислений по оборудованию,
А0 = 10%;
 - действительный
годовой фонд времени работы оборудования, ч;з - коэффициент загрузки
оборудования.
- действительный
годовой фонд времени работы оборудования, ч;з - коэффициент загрузки
оборудования.
Годовой фонд времени работы оборудования, ч
Fоб = [(Dк - dнр)
tсм - dск tск] mсм;
(8)
Откуда
об=
[(365-108)∙8-6∙1]∙2 = 4100, ч
Годовой фонд времени явочного рабочего, ч
Fяв=
Fоб/mсм;
(9)
ОткудаFяв=
Fоб/mсм
=
4100/2 = 2050, ч.
Стоимость оборудования
рассчитывается по формуле

где Ц0 - оптовая цена для
необходимого оборудования (вакуумная камера), Ц0=200000000 руб.;
kт.м -
коэффициент, учитывающий расходы на транспортировку и монтаж
оборудования.
Коэффициент загрузки
высокочастотной
установки рассчитывается по формуле

где N
- производственная программа, N=50000
шт.;
Qп
- потребное количество оборудования, Qп
=1
шт.
Для толщины 2

Для толщины 3

Амортизационные отчисления по оборудованию
Для толщины 2

Для толщины 3

Затраты на текущий ремонт и на межремонтное
обслуживание оборудования

Для толщины 2

Для толщины 3

Затраты на амортизацию, ремонт,
освещение, уборку помещения принимаем равными 20%
от основной заработной платы производственных рабочих

Для покрытия толщиной 2

Для покрытия толщиной 3

При технологии нанесения антибактериального
серебросодержащего покрытия толщиной 2 себестоимость изготовления покрытия
составляет:

При технологии нанесения антибактериального
серебросодержащего покрытия толщиной 3 себестоимость изготовления покрытия
составляет:

Разница между двумя технологиями нанесения
антибактериального серебросодержащего покрытия

Разница между двумя технологиями нанесения
антибактериального серебросодержащего покрытия толщины 2 и толщины 3 в 1.6
раза.
Годовой экономический эффект от внедрения новой
технологии с учетом увеличения срока службы изделий рассчитывается по формуле

где З1, З2 -
приведенные затраты на изготовление единицы продукции, руб.;
Т1,Т2 -
срок службы изделий, Т1,=5 месяцев, Т2 =3 месяца;
А производственная программа, А = 4100 шт.
Приведенные затраты
 (15)
(15)
где Ен -
нормативный коэффициент капитальных вложений, Ен=0,15;
К1,К2 - удельные
капитальные вложения, руб.[16].

Приведенные затраты для старой и новой
технологии
 ;
;

Экономический эффект от внедрения новой
технологии с учетом увеличения срока эксплуатации деталей

Экономический расчет с учетом выбора оптимальной
толщины серебросодержащего покрытия по критерию биосовместимости и высоких
антибактериальных свойств.
Экономический эффект рассчитан при сравнении
толщин покрытия 2 и 3 на 50000 изделий. Экономия составила 36% процентов
6. Меры
техники безопасности и экологические аспекты технологии
6.1 Меры
техники безопасности при работе на электроустановках
. Общие требования
К работе на установках допускаются лица,
прошедшие медицинский осмотр, местный инструктаж по безопасности труда,
изучившие техническое описание установок, инструкцию по эксплуатации,
инструкцию по технике безопасности при работе на данном оборудовании, изучившие
данный комплект документов, имеющие удостоверение на право работы на
электроустановках с напряжением выше 1000 В .
Для выполнения работ необходимо соблюдение
требований по технике безопасности и охране труда в соответствии с:
"Правила по технике безопасности и производственной санитарии в электронной
промышленности, "Правила технической эксплуатации электроустановок
потребителей" и "Правила техники безопасности при эксплуатации
электроустановок".
.1 На участке может работать смена не менее чем
из двух человек, имеющих квалификационную группу по технике безопасности не
ниже четвертой.
.2 Запрещается работа на установке без вытяжной
вентиляции.
.3 Ремонтные и наладочные работы разрешается
проводить бригаде, состоящей не менее чем из двух человек с разрешения
начальника участка, обеспечивающего все организационные и технические
мероприятия для безопасной работы.
.4 В помещении технологического участка уборка
должна производиться влажным способом при полном снятии напряжения и в
присутствии кого-либо из персонала участка.
. Правила электробезопасности
.1 Установка модели УВН - 71М должна быть
заземлены голым медным проводом площадью поперечного сечения не менее 4 мм2.
.2 Запрещается работать при снятых обшивках,
кожухах, открытых дверях установки.
.3 Запрещается включать импульсный
высоковольтный генератор
- без подключенного блока активации.
- при открытой крышке блока активации.
- при зазоре между электродом и валом
более 2 мм.
- при нарушении изоляции
высоковольтного кабеля или диэлектрического покрытия на валу блока активации
2.4 Запрещается выключать питание установки при
включенном импульсном высоковольтном генераторе
.5 Запрещается оставлять без наблюдения
установку, находящуюся под напряжением.
Правила пожаробезопасности
.1 Легко воспламеняющиеся жидкости (ЛВЖ) должны
храниться в небьющейся, герметически закрытой посуде и таре.
.2 Запас ЛВЖ на рабочем месте не должен
превышать потребности на одну смену.
.3 Обтирочный материал должен храниться в
специальных металлических ящиках с закрывающимися крышками.
.4 Запрещается включать импульсный высоковольтный
генератор
- при наличии воспламеняющихся предметов или
веществ внутри блока активации
- при наличии капель любой жидкости на
поверхности электрода или вала в блоке активации.
3.5 Работающим на участке запрещается работать
при отсутствии проверенных средств защиты пожаротушения
6.2 Меры
техники безопасности при работе с вакуумными установками
При работе с вакуумными установками могут
возникать следующие виды опасности производственных факторов: электроопасность,
пожароопасность, термоопасность, опасность химических ожогов.
Для предупреждения поражения электрическим током
следует предусмотреть: надежное заземление корпуса установки и высоковольтного
блока питания; надежную изоляцию внешней электропроводки; ограждение всех
доступных для прикосновения токопроводящих частей; выполнение правил устройства
электроустановок.
При перерывах подачи электроэнергии, или выхода
из рабочего помещения необходимо установку выключать. Не оставлять без
присмотра установку, находящуюся под напряжением. При работе с жидким азотом
следить, чтобы брызги азота не попадали на незащищенные участки тела. Соблюдать
режимы работы установки согласно техническим требованиям, предъявляемым к ней.
Не работать при снятых щитках установки и открытых дверях шкафа управления.
Соблюдать осторожность с нагретыми частями установки во избежание ожогов
(нагреватель паромасляного насоса, подложки).
Вследствие высоких энергий и температур,
развивающихся при ионной обработке, выделяются газы, пары и аэрозоли,
повышающие содержание вредных веществ в воздухе. Поэтому необходимо
осуществлять мероприятия, в результате которых содержание вредных веществ в
зоне дыхания работающего снижается до предельно допустимых концентраций. К
основным из них относятся:
) внедрение прогрессивных технологий,
герметизированного оборудования, низкотоксичных материалов, исключающих, или
ограничивающих выделение вредных веществ и попадания их в рабочую зону;
) применение приточно-вытяжной вентиляции и
кондиционирования воздуха;
) использование ловушек и фильтров вредных
веществ в зонах их выделения, не допуская их распространения по всему помещению
и попадания в атмосферу.
Во избежание поражения ионизирующим излучением
при ионной обработке толщина стенок вакуумной камеры должна соответствовать
нормам, а в смотровые окна должны быть вмонтированы свинцовые стекла
соответствующей толщины.
На протяжении ряда лет вакуумные процессы
считались экологически чистыми и практически безопасными для обслуживающего
персонала. Ситуация изменилась в связи с широким внедрением в практику плазменных
методов травления и активации поверхности, нанесения тонких пленок, процессов
полимеризации и химических методов осаждения пленок из газовой фазы. Реакции,
происходящие в плазме, приводят к образованию агрессивных, токсичных и
взрывоопасных соединений. Если в лабораторных исследовательских установках их
количество незначительно, то при переходе к
промышленному производству необходимо применять специальные средства
безопасности.
Наибольший интерес представляют следующие
плазмохимические процессы:
) вызывающие образование агрессивных соединений,
приводящих к коррозии элементов конструкции вакуумных установок и к деградации
вакуумных масел;
) в результате которых образуются взрывоопасные
смеси, способные создавать аварийную ситуацию;
) приводящие к образованию токсичных веществ,
представляющих опасность для персонала, обслуживающего оборудование и
проводящего его профилактику.
В плазмохимических процессах участвуют различные
газы. Особенно опасны утечки этих газов в производственных помещениях.
При испарении и распылении полимеров образуется
большой спектр продуктов разложения.
При профилактике вакуумных камер следует
максимально исключить прямой контакт пыли металла или его соединения с кожей.
Токсичная пыль и аэрозоли накапливаются в изгибах откачных патрубков, а также в
маслах насосов. Кроме того в маслах растворяются токсичные и взрывоопасные
газы, а фтор и хлор водороды с парами воды образуют очень агрессивные кислоты.
Причем концентрация вредных веществ может значительно превышать ПДК. Применение
охлаждаемых жидким азотом ловушек, активированного угля и силикагелей частично
решает проблему защиты масла форвакуумного насоса.
Заключение
В дипломном проекте определены преимущества
серебросодержащего антибактериального покрытия сформированного из активной газовой
фазы.
Выяснили, что вакуумный метод нанесения
позволяет наносить наночастицы серебра заданной концентрации на подложку любой
природы в том числе и на пористые материалы.
Представлена схема осаждения покрытий из
активной газовой фазы, фото электронного просвечивающего микроскопа, для
микроскопических исследований и устройство для проверки на биосовместимость,
которые позволили нанести покрытия различной толщины (5, 20, 50 нм ) и
проверить биосовместимы ли покрытия. А так же была изучена Методика микробиологических
исследований, позволяющая визуально определить, по наличию (+) или отсутствию
(-) роста в местах нанесения суспензий тест-культур.
При проведении исследований были получены
следующие результаты: покрытия полученные плазмохимическим методом обладают
бактериоцдным (отсутствие колоний роста ) и бактериосттическими свойствами
(уменьшение площади колоний роста ) к бактериям типа: золотистый стафилококк -
S.a., кишечной палочки -E.c., Кандидоз (молочница) - C.a.
Наилучшие бактериоцдным свойства (отсутствие
колоний роста ) обладает образец 3(50 нм).
Образец 1, 2 обладают биосовместимостью к
(ампуляриями), в то время как образец 3 не обладают биосовместимостью к
(ампуляриями).
Данные яркости фильтрующих элементов с покрытием
1 существенных различий в яркости не выявили
Данных яркости фильтрующих элементов
показывающий способность покрытия к подавлению роста бактерий и грибов позволил
установить, что образец 2 обладает на пятый день в 1.1 раза большей яркостью
чем ПП-волокно без покрытия. Из-за роста, на фильтрующем элементе, бактерии и
грибков, в конце яркость отличается в 4 раза.
Разработан технологический процесс нанесения
антибактериальных серебросодержащих покрытий на картридж фильтра, включающий
входной контроль, нанесения покрытия, контроль толщины покрытия, контроль
качества продукции.
Был проведен экономический расчет с учетом
выбора оптимальной толщины серебросодержащего покрытия по критерию
биосовместимости и высоких антибактериальных свойств. Экономический эффект
рассчитан при сравнении толщин покрытия
2 (20 нм) и 3 (50нм) на 50000 изделий. Экономия составила 36 %.
Из полученных результатов следует, что
применение серебросодержащего покрытия толщиной 2 (20 нм) позволяет получить
высокие антибактериальные свойства при меньших затратах на изготовление единицы
продукции.
Вывод
-Разработана методика нанесения
антибактериальных биосовместимых покрытий содержащих наночастицы серебра.
- Установлены высокие антибактерицидные свойства
таких покрытий к резистентным микроорганизмам и водным грибкам.
Определены оптимальные толщины синтезируемых
покрытий по критерию биосовместимости и высоких антибактериальных свойств.
- Разработан технологический процесс нанесения
антибактериальных покрытий на очистной картридж водяного фильтра и рассчитан
экономический эффект применения данного покрытия
Литература
. http://www.helsinki.fi/ журнал
Colloid and Polymer Science.
2. Валерий Шулаев, Валерий Тырнов
"Наука и технология"., 2010г
. www.upackgroup.ru
Группа компаний УПАК © 2010
4.Рогачев А.В., Сидорский С.С. Восстановление
и повышение износостойкости деталей машин. Гомель 2005, 343 стр
5. nss4@yandex.ru,
ООО "Прикладная Электроника
. А.И. Коротин. "Технология
нанесения гальванических покрытий" Москва " Высшая
школа"1989год, 195 стр.
. Никитин М.М. Технология и оборудование
вакуумного напыления. - Москва: Металлургия, 1992.
. Белый А.В., Карпенко Г.Д., Мышкин
Н.К. Структура и методы формирования износостойких поверхностных слоев. -
Москва: Машиностроение, 1991.
9. В.С. Ковивчак
" Физика" ежемесячный научный журнал. Томск, 2008 под редакцией
Суржикова А.П. стр. 2008, авторы:. том 51
10.Авторский проект O8ODE.RU,
kolloidnoe nanocerebro produkt nanotehnologii.htm
11. Ковивчак В.С, Бурлаков Р.Б,
панова Т.В, Давлеткильдеева Н.А. // Письма в ЖТФ- 2008. - т34- Вып 8.- с 85-91.
12. Борен К.,
Хафмен Д. Поглощение света малыми частицами. -М.: Мир, 1986. -664 с.
. Zelenina
A.S.., Quidant R., Nieto- Vesperinas M//Opt.lett/-2007/-V.32.-No.9.-P.
1156-1158.
. Hu. J.,Cai
W., Li Y., and Zeng H.// J. Phys: Condens. Matter.-2005.-V.17.-
P.5346-5354.
16. Методика определения
экономической эффективности использования в народнгом хозяйстве новой техники,
изобретений и рационализаторский предложений / Гос. комитет СССР по делам
изобретений и открытий. - М.
:
ВНИИПИ.
1981.
- 23 с.
17. Grier, N. Silver and its
compounds. In Disinfection, Sterilization and Preservation. Third Edition.
Philadelphia, Lea & Febiger, 1983.375-389
. Cliver, DO, et al.,
"Biocidal Effects of Silver: Contract NAS 9-9300 Final Technical
Report", University of Wisconsin, February 1970; p.5.
19. Толгская М.С., Чумаков А.А.
Аргироз// Большая медицинская энциклопедия/ Под ред. Петровского Б.В. - 3- е
изд. - М.: Советская энциклопедия, 1984 - Том 2, С. 142-143.
. Савадян Э.Ш., Мельникова В.М.,
Беликов Г.П. Современные тенденции использования серебросодержащих
антисептиков// Антибиотики и химиотерапия. - 1989. - т. 34. - №11. - С.
874-878.
21.
Toxicity And Fate Of Silver In The Environment.
// Environmental Toxicology and Chemistry, V. 17, N4, April 1998, 539-649 pp.
. Ratte HT. Bioaccumulation and
toxicity of silver compounds: A review. // Environmental Toxicology And
Chemistry; 1999. 18 (1). 89 - 108.
. Guggenbichler, J.P., M.
Boswald, S. Lugauer, and T. Krall. A new technology of microdispersed silver in
polyurethane induces antimicrobial activity in central venous catheters. //
Infection, 1999, 27, Supp. 1, 16-23.
. Fung M.C., Bowen D.L. Silver
products for medical indications: risk-benefit assessment. // J Toxicol Clin
Toxicol. 1996; 34(1): 119-26.
. US Patent 5,651,978 Tomioka,
et al. July 29, 1997. Silver thiosulfate silica gel antibacterial antibacterial
compositions
26. Berry D.B. 2nd, Sullins
K.E. Effects of topical application of antimicrobials and bandaging on healing
and granulation tissue formation in wounds of the distal aspect of the limbs in
horses. // Am J Vet Res. 2003 Jan;64(1):88-92.
27. Tokumaru, T., Shimizu, Y.,
and Fox, C.L. Jr. Antiviral activities of silver sulfadiazine in ocular
infection. // Research Communications in Chemical Pathology and Pharmacology,
1974.8(1), 151-158.
. Monafo W.W., West M.A.
Current treatment recommendations for topical burn therapy. // Drugs. 1990
Sep;40(3):364-73.
. Noronha C., Almeida A. Local
burn treatment - topical antimicrobial agents. // Annals of Burns and Fire
Disasters. Dec. 2000, vol.XIII, N.4, p.236.
30. Bult, Auke. Silver
sulfadiazine and related antibacterial metal sulfanilamides: facts and fancy.
// Pharmacy International, 1982 December, 400-404.
. Gerald McDonnell and A.
Denver Russell Antiseptics and Disinfectants: Activity, Action, and Resistance.
// Clinical Microbiology Reviews, January 1999, Vol. 12, No.1, p. 147-179.
32. Fox C. Silver sulphadrazine
- a new topical therapy for pseudomonas in burns. // Arch Surg. 1968;96:184.
. US Patent 3,761,590. Fox, Jr.
Sept 25, 1973 Silver Sulfadiazine used in the treatment of burns
. Charles L. Fox, Jr., And Shanta
M. Modak. Mechanism of Silver Sulfadiazine Action on Burn Wound Infections. //
Antimicrobial Agints And Chemotherapy, 1974, June, Vol. 5, No. 6, P. 582-588.
35. Carr, Howard S.,
Wlodkowski, Theodore J., and Rosenkranz, Herbert S. Silver sulfadiazine: in
vitro antibacterial activity. // Antimicrobial Agents and Chemotherapy,
1973.4(5), 585-587.
36. Kucan, John O., et al.
Comparison of silver sulfadiazine, povine-iodine and physiologic saline in the
treatment of chronic pressure ulcers. // Journal of the American Geriatrics
Society, 1981.29(5), 232-235.
37. Berry D.B. 2nd, Sullins
K.E. Effects of topical application of antimicrobials and bandaging on healing
and granulation tissue formation in wounds of the distal aspect of the limbs in
horses. // Am J Vet Res. 2003 Jan;64(1):88-92.
38. Geronemus RG, Mertz PM,
Eaglstein WH. Wound healing. The effects of topical antimicrobial agents. //
Arch Dermatol 1979; 115(11): 1311-4
39. B. Fowler & G.
Nordberg. Silver. // Handbook on the Toxicology of Metals, L. Friberg, G.
Nordberg & V. Vouk, eds. Amsterdam: Elsevier Sci. Pub., 1986, Vol. 2,
521-31.
40. Marshall J.P. 2nd,
Schneider R.P. Systemic argyria secondary to topical silver nitrate. // Arch
Dermatol. 1977 Aug;113(8):1077-9.
. Rosenman K.D., Moss A., Kon
S. Argyria: clinical implications of exposure to silver nitrate and silver
oxide. // J Occup Med. 1979 Jun;21(6):430-5.
42. Kettner W., Vogel K.,
Kruger G. // Dtsch. Gesundheitsw., 1970, 25, N 37, S. 1746-1747
43. Зайченко
А.И.,
Чижов
С.В.,
Эльпинер
Л.И.
// Здоровье,
1975, №2, с.10-11
44. Тарала Г.Т. // Журн.
Экспериментальной и клинической медицины, 1970, 10, № 4, с.64-67
45. Сорока В.Р., Вуль Ф.Р., Щербаков
А.Я. // Вопр.неврологии и психиатрии, 1968, с.161-162
46. Зак В.И., Попов В.Н. //
Микроэлементы в медицине, 1973, вып. 4, с.78-81
47. Сорока В.Г., Зак В.И. //
Отоларингология, 1973, вып. 4, с.73-75
48. Войнар А.И. Микроэлементы в
живой природе. М., "Высш. Школа", 1962.
49. Уэбб Л. Ингибиторы ферментов и
метаболизма. М., "Мир", 1966, с.550.
50. Chappel J.B., Grevilles
G.D. // Nature, 1954, v.174, N 13, p.930-931
51. Лазаренко Д.И., Чижов С.В.,
Козыревская Г.И., Гайдамакин Н.А., Ермаковский Н.Д. О токсичности воды,
обогащенной ионами серебра // Гигиена и санитария. - 1964. - №2. - С. 98-100
. Нежинская Г.И., Копейкин В.В.,
Гмиро В.Е. Иммунотропные свойства высокодисперсного металлического серебра. //
Препринт №4 "Серебро в медицине и технике". - Новосибирск:
Издательство СО РАМН. - 1995 . - С. 151-153.
53. Венчиков А.И. Биотики. М.,
Медгиз, 1962
54. Применение посеребренных
препаратов проф. С.В. Мойсеева в медицине. Сб. работ под ред. Проф. И.Я.
Вольфсона и др. Изд-во 2-го Ленингр. Мед.ин-та, 1937, с.61-62
55. Щербина А.В. // Радянська
медицина, 1937, № 8, с.63-69
56.Лазаренко Д.И., Чижов С.В.,
Козыревская Г.И. и др. // Гигиена и санитария, 1964, № 2, с.98-100.
57. Харченко П.Д., Бердышев
Г.Д., Степаненко П.З., Великоиваненко О.О. // Фiзiологiчний
журнал, 1972, 18, № 5, с.596-600.
58. Уэбб Л. Ингибиторы ферментов и
метаболизма. М., "Мир", 1966, с.550
59. Скворцов В.И. Курс фармакологии.
М.-Л., Биомедгиз, 1948.
60.Колесникова Г.С. - Материалы
респ. Научн. Конф. По проблеме "Лечение и диагностическое применение
радиоактивных изотопов" 10-12 июня 1968 г., К., 1968, с.130-132
.Цилюрик И.Т. // Новый хирург.
Архив, 1958, № 3, с. 46-49
.Пак З.П., Петина В.П. //
Водоподготовка и очистка промышленных стоков, 1973, вып. 10, с.80-83.
.Новикова А.В., Пак З.П. //
Водоподготовка и очистка промышленных стоков, 1973, вып.10, с.78-80
.Павленко С.И., Крастина Э.М.,
Постникова Е.К., Черняк Ю.А. // Вопросы эксперим. И
клинич.
Радиологии,
1966, с.177-181.
65. Cervantes C, Chavez K, Vaca
S. Mechanisms of bacterial resistance to heavy metals. // Rev Latinoam
Microbiol. 1991 Jan-Mar;33(1):61-70.
. US Patent 6123925. Barry;
John E.; Trogolo; Jeffrey A. Antibiotic toothpaste July 27, 1998
. American Conference of
Governmental Industrial Hygienists, Inc. Documentation of the Threshold Limit
Values, 4th ed., 1980. Cincinnati, Ohio: American Conference of Governmmental
Industrial Hygienists, Inc., 1980., p. 367
. US Patent 5688492. E.Galley,
M.D. Cooper. Oral hygiene composition. 1997-11-18
. Agency for Toxic Substances
and Disease Registry: Toxicological Profile for Silver - CAS# 7440-22-4, Dec.
1990.
. Drake, Pamela L.; Hazelwood,
Kyle J. Exposure-Related Health Effects of Silver and Silver Compounds: A
Review. // Annals of Occupational Hygiene. October 2005.49(7):575-585
. Брызгунов
В.С.,
Липин
В.Н.,
Матросов
В.Р.,
Наумовна
Е.К.
// Науч.труды
Казан.
Мед.
Ин-та,
1964, № 14, с.38-42
72. US Patent Application
20050061678. Holladay, Robert J.; et al. Treatment of humans with colloidal
silver composition. March 24, 2005
73. Д.Синдо, Т.Оикава. Аналитическая
просвечивающая электронная микроскопия для материаловедения. - M.,
Мир, 2006, 256 c.
. www.tokyo-boeki.ru